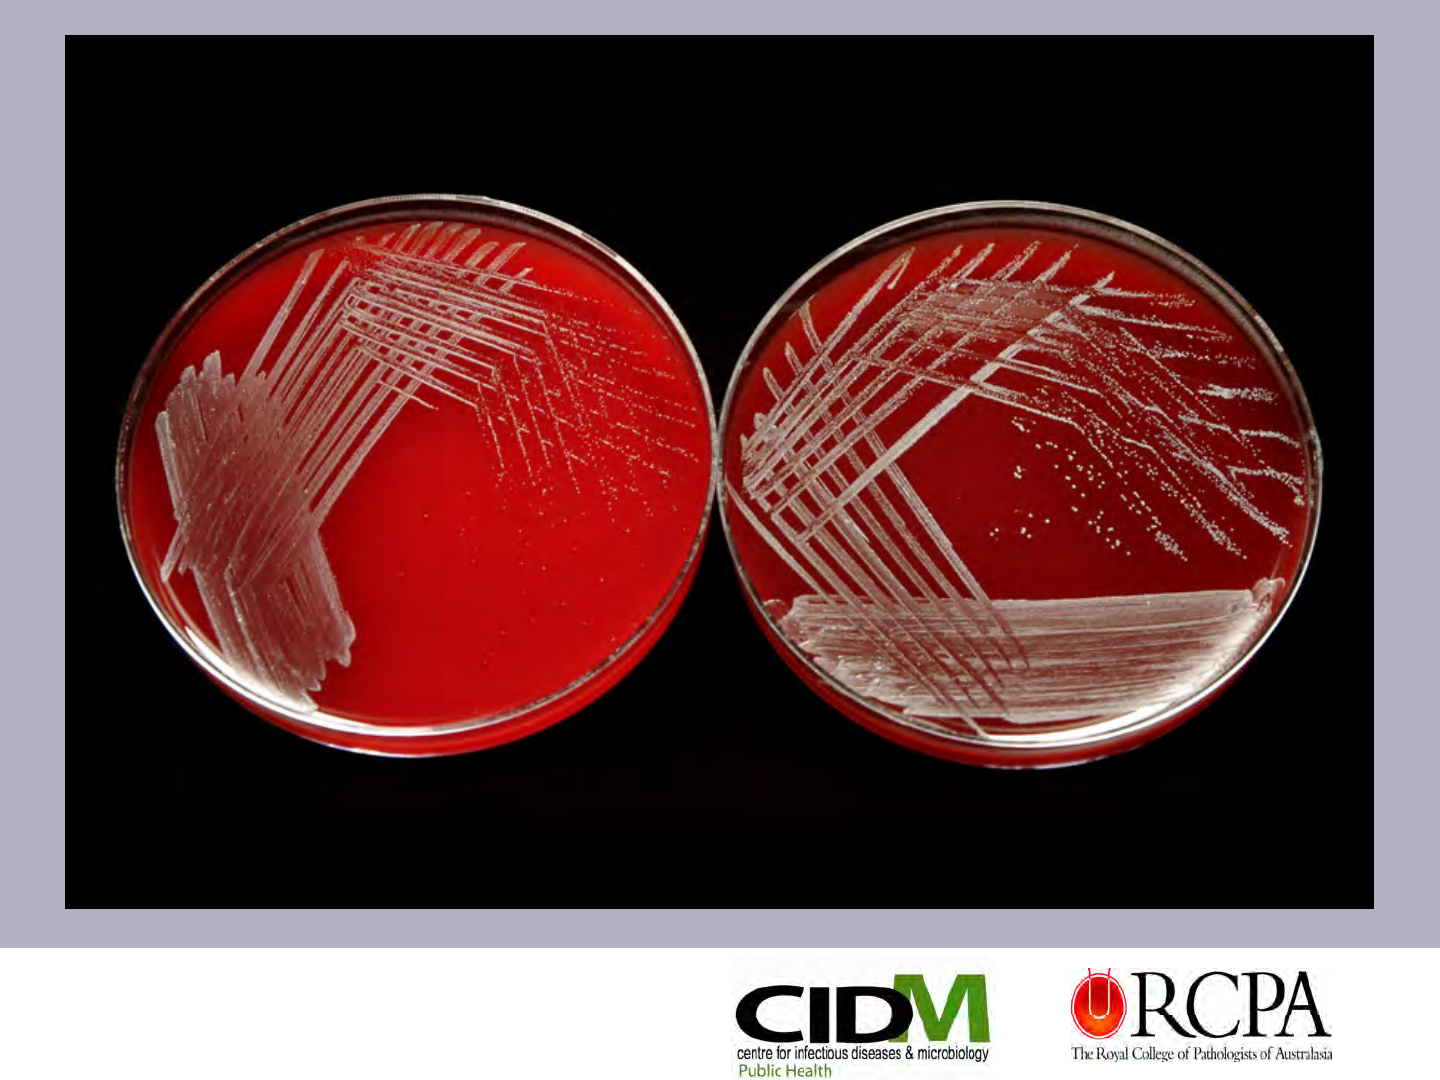
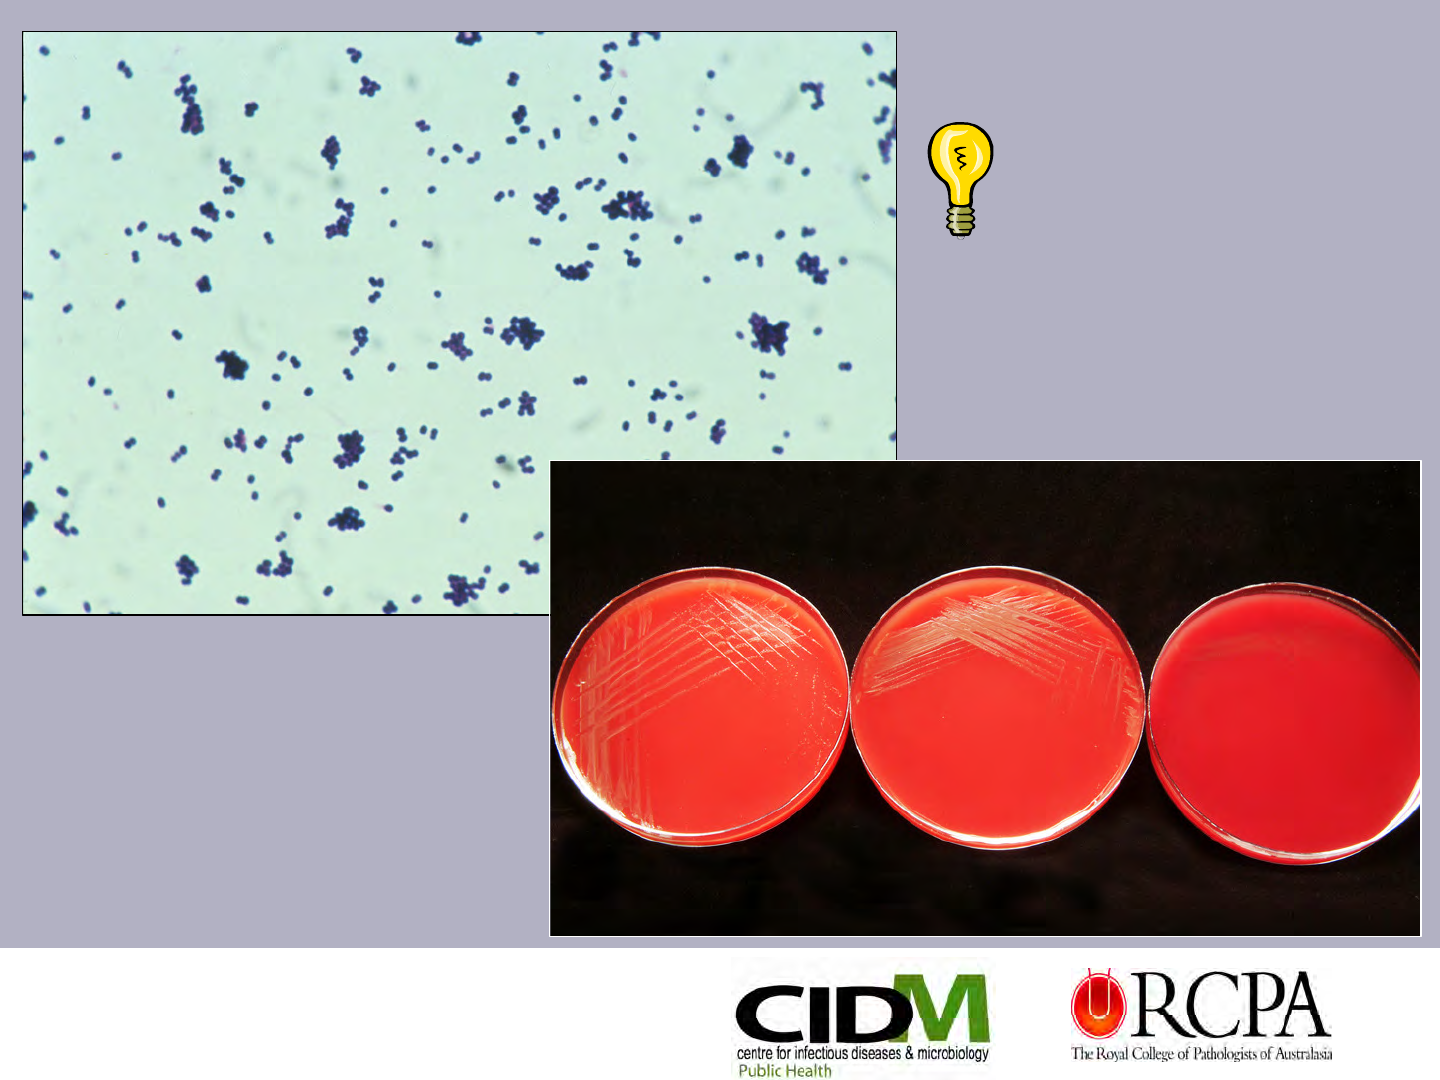
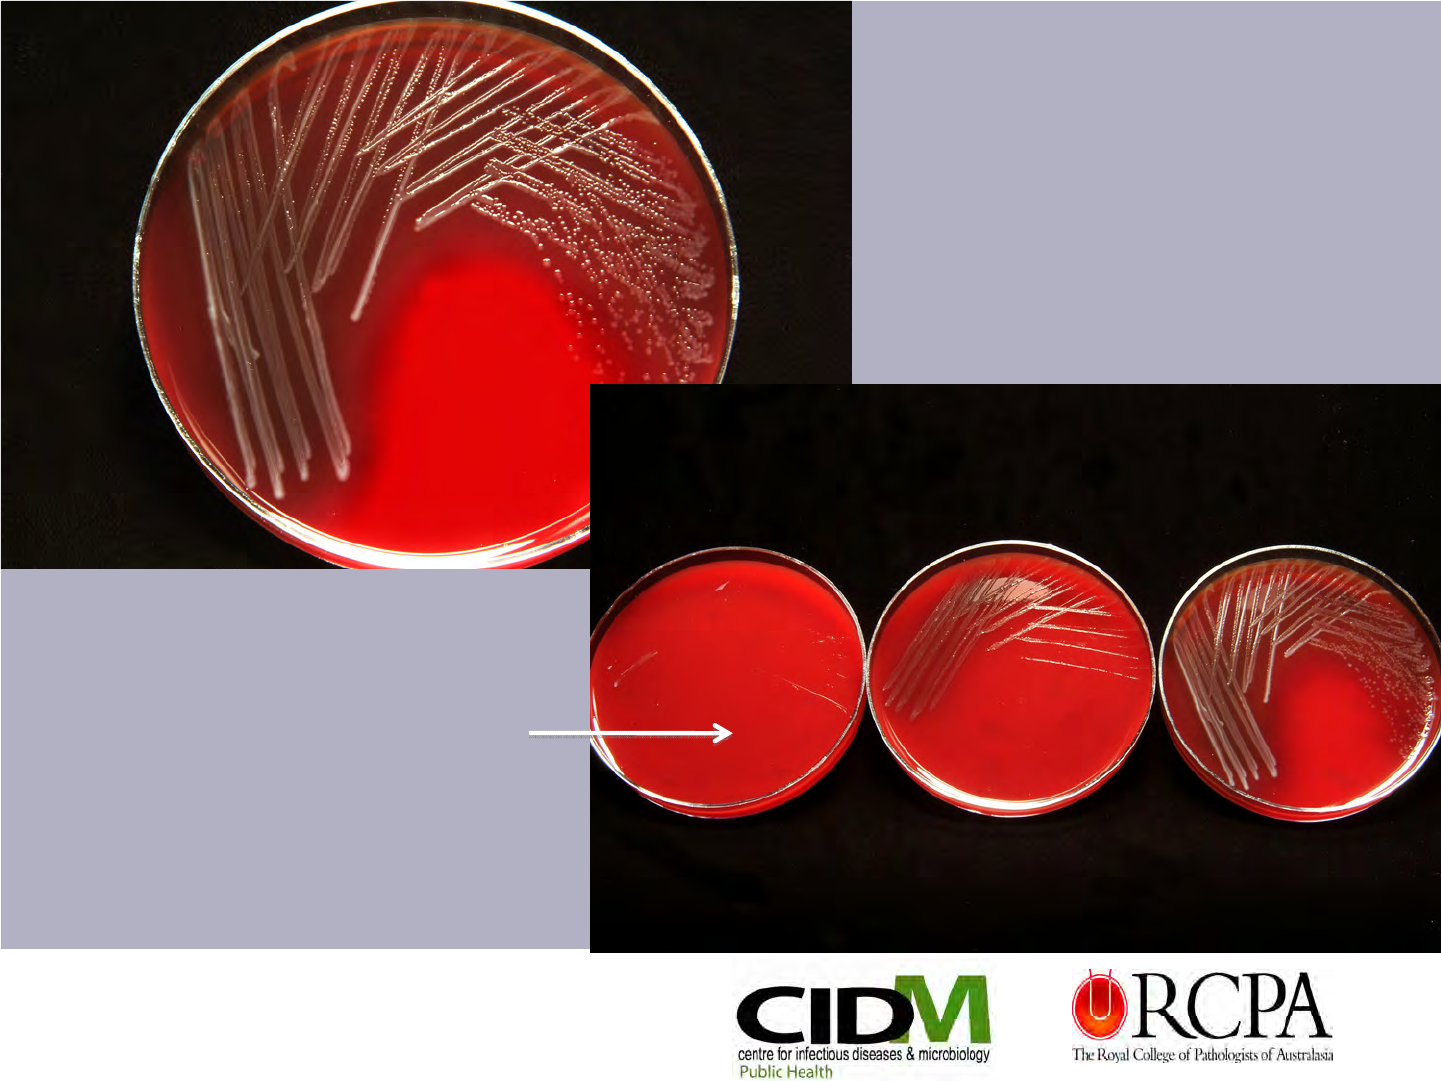
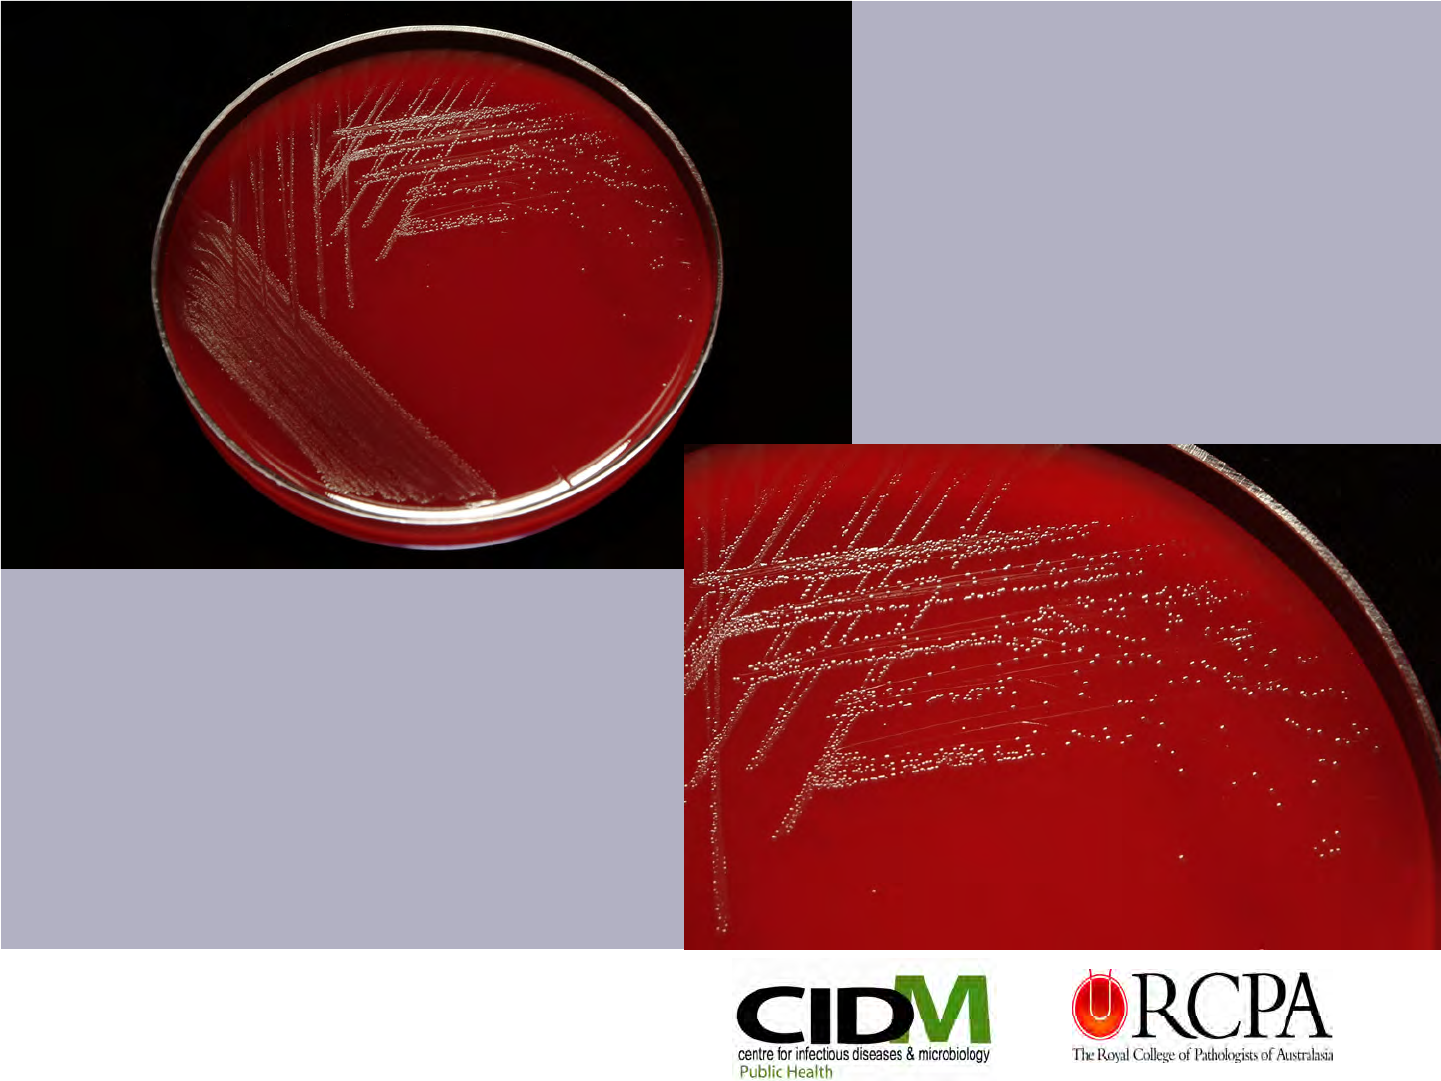
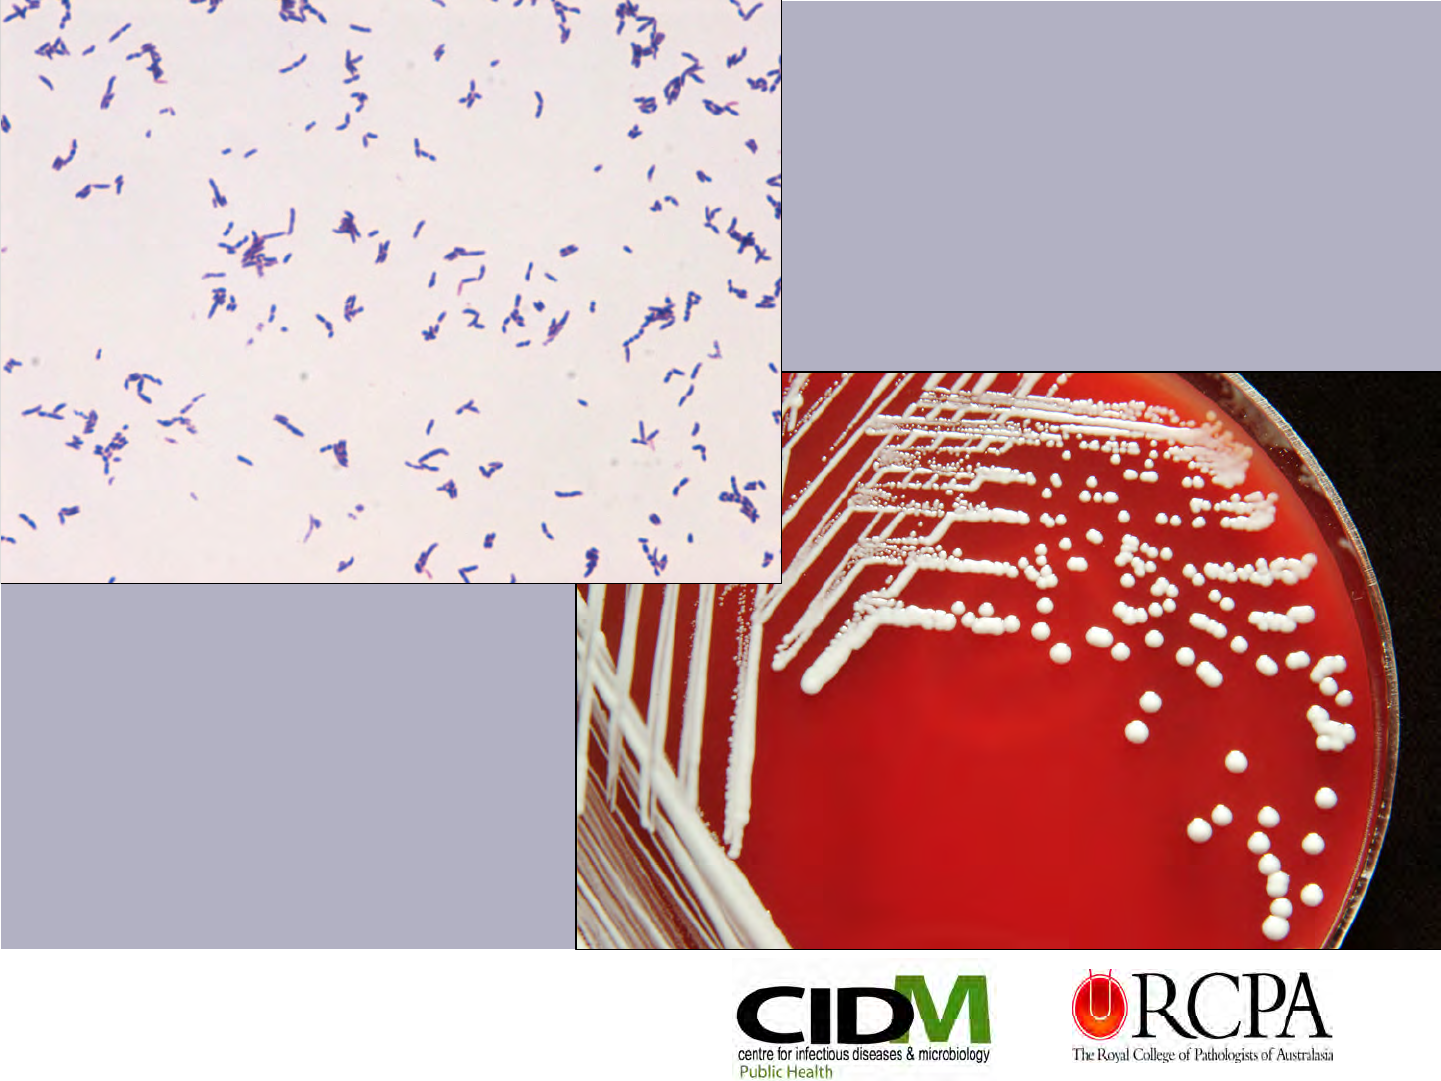
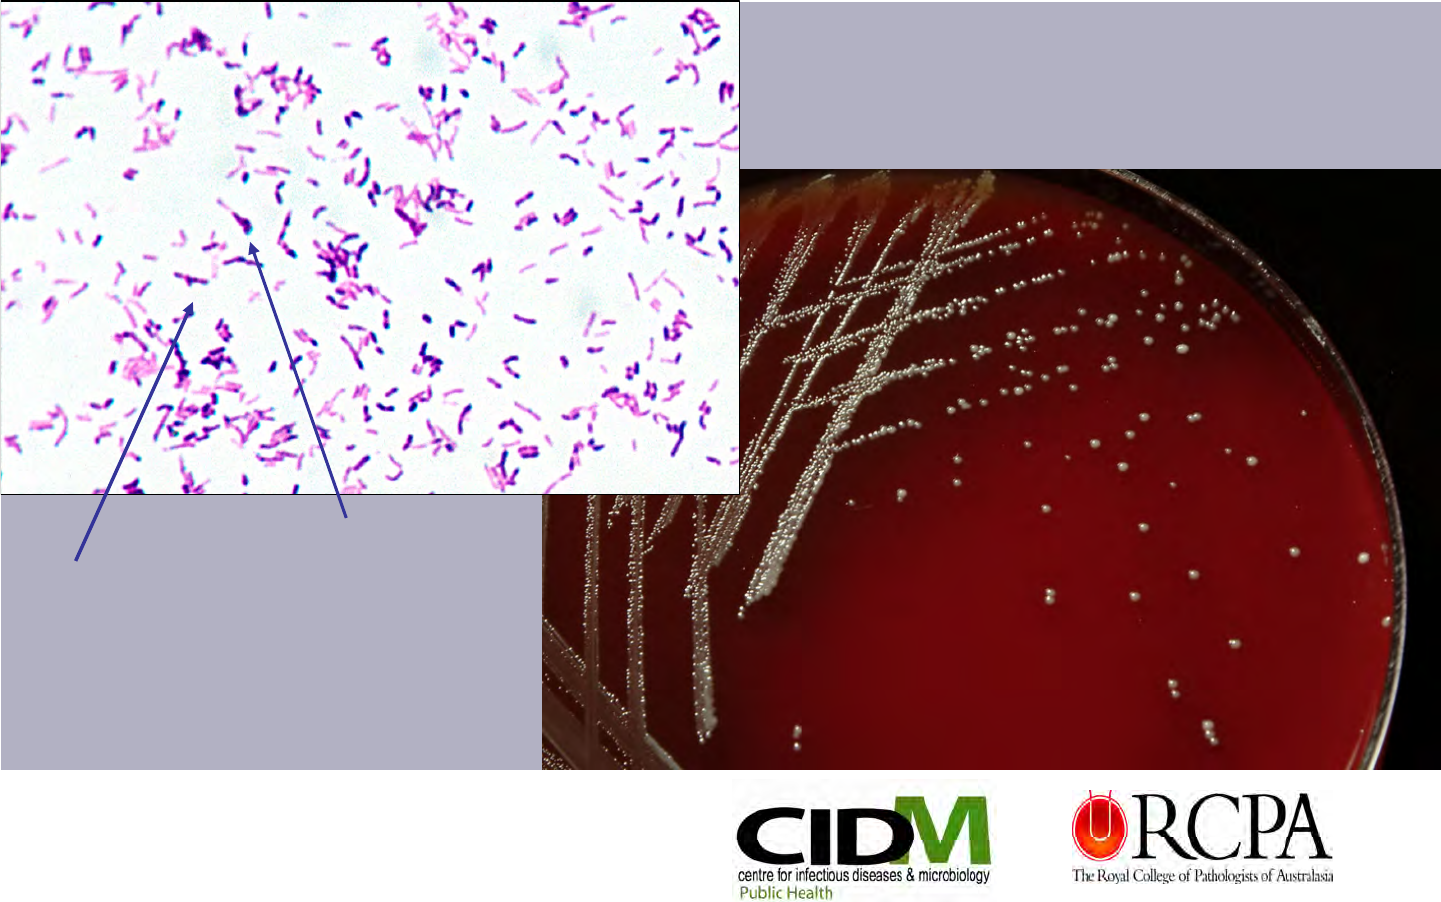
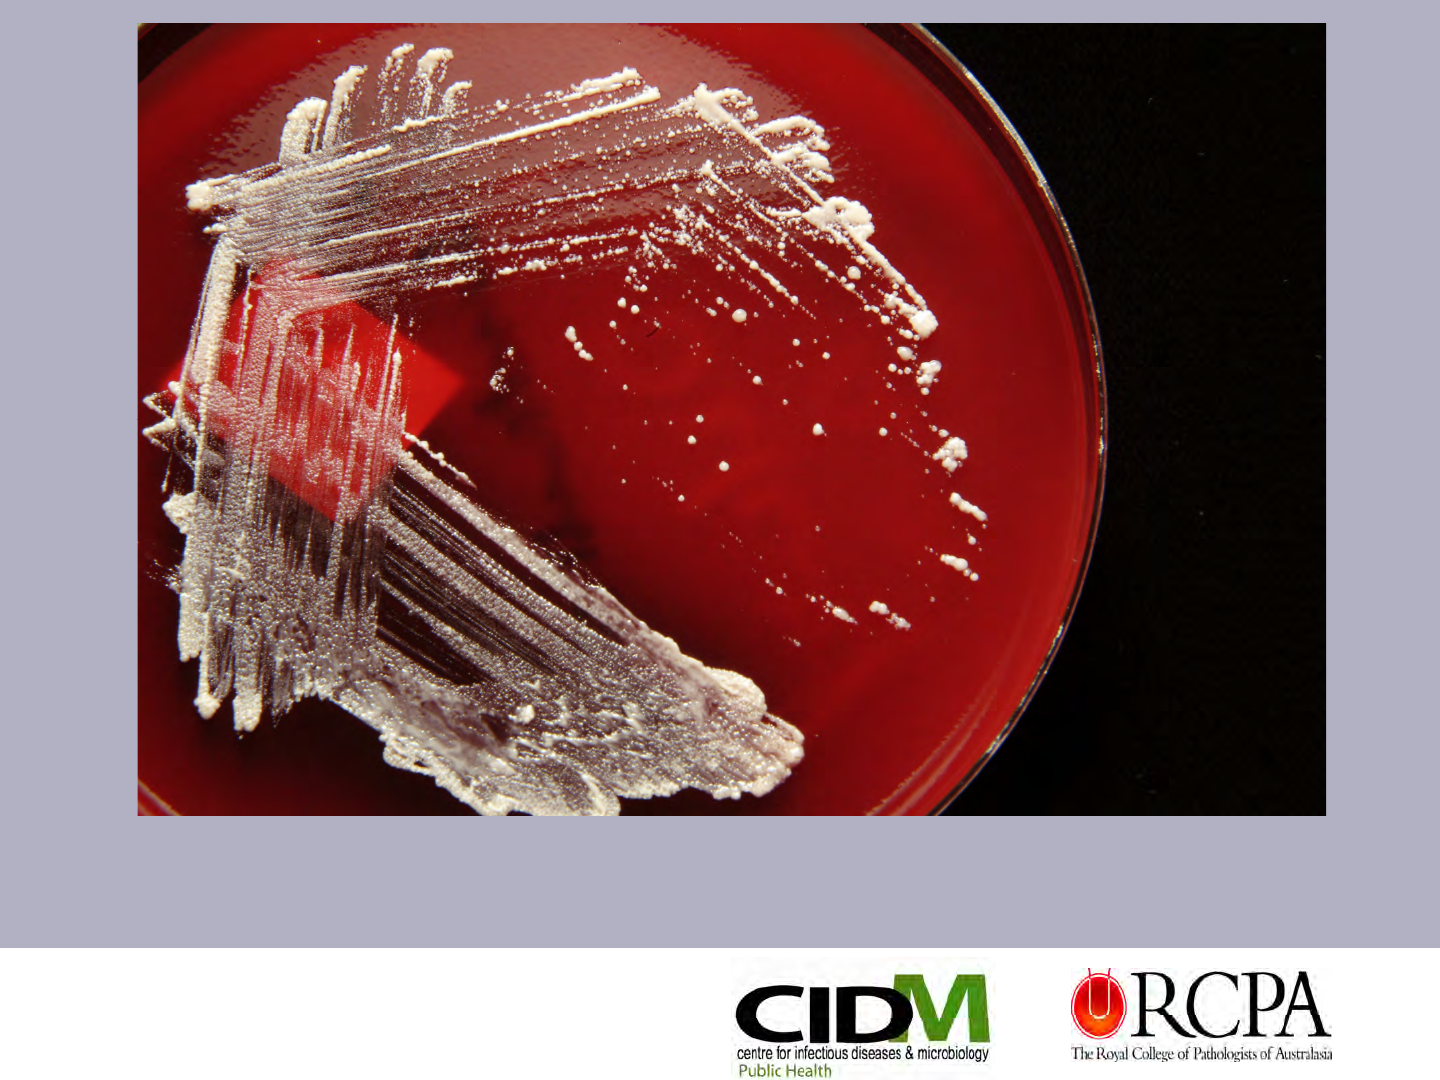
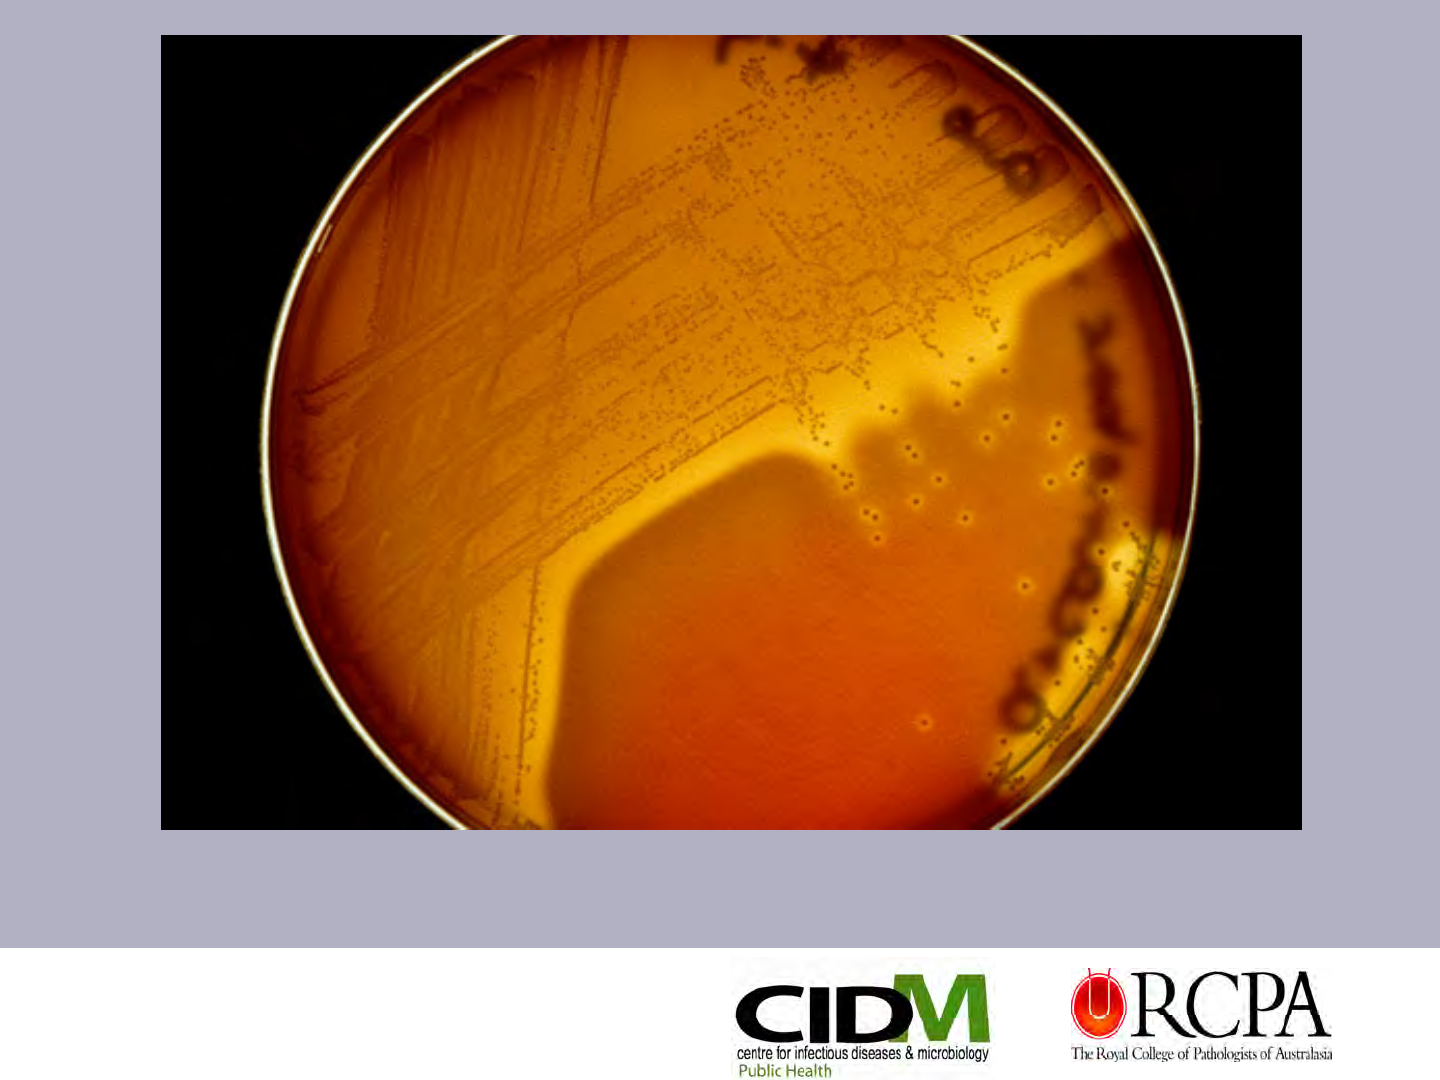
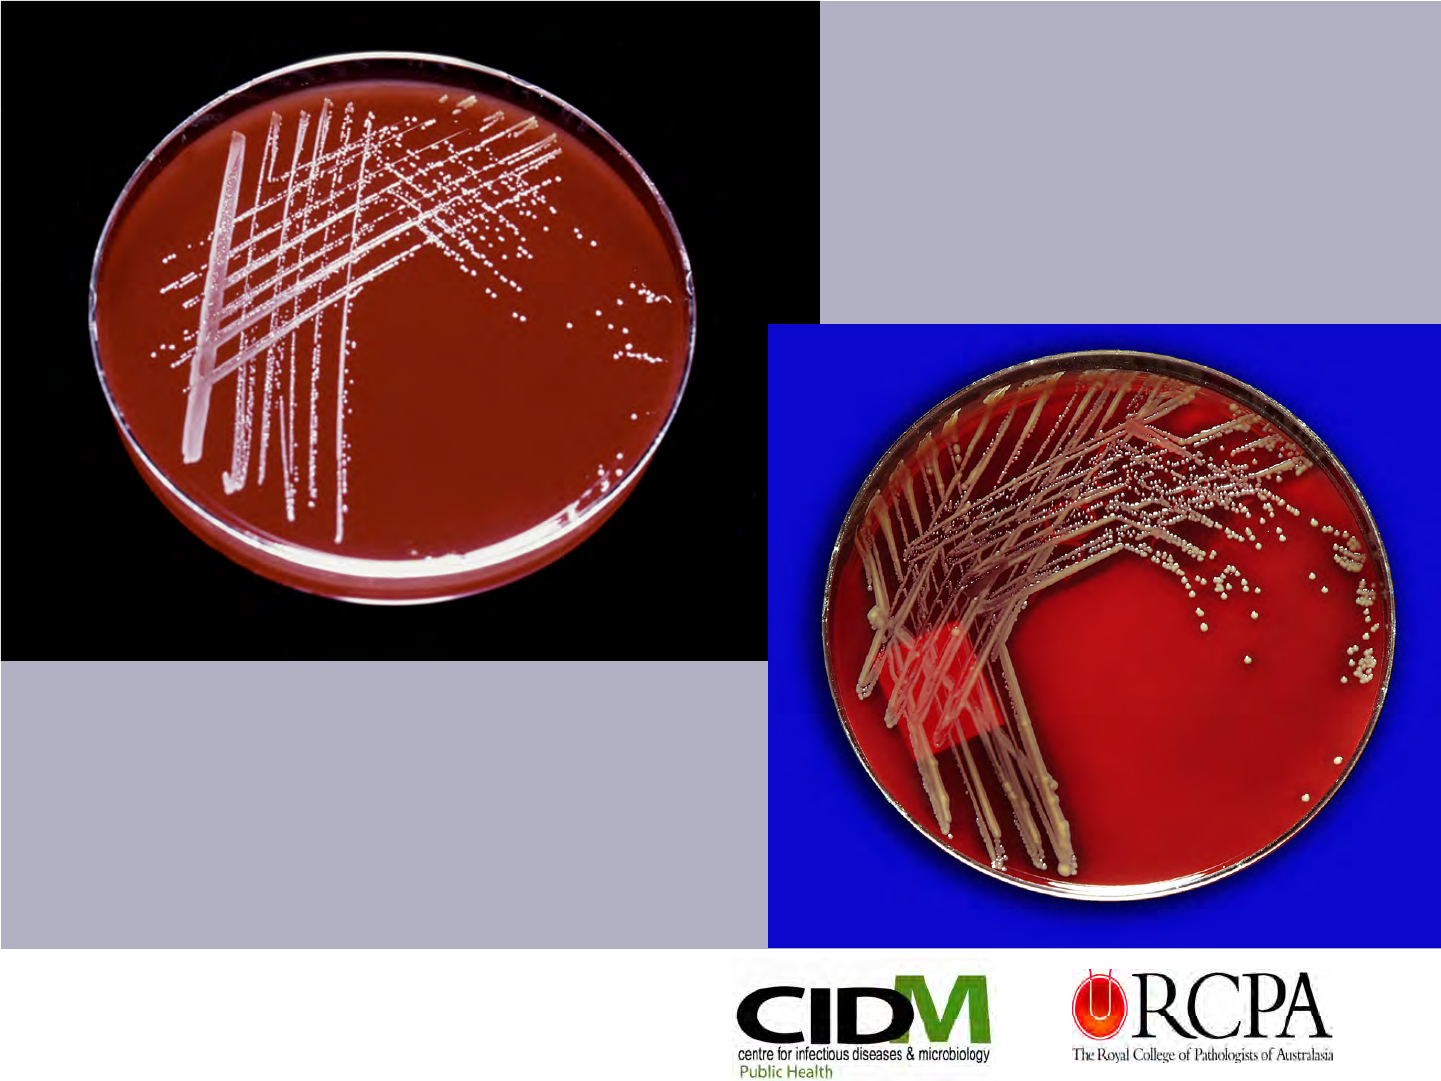
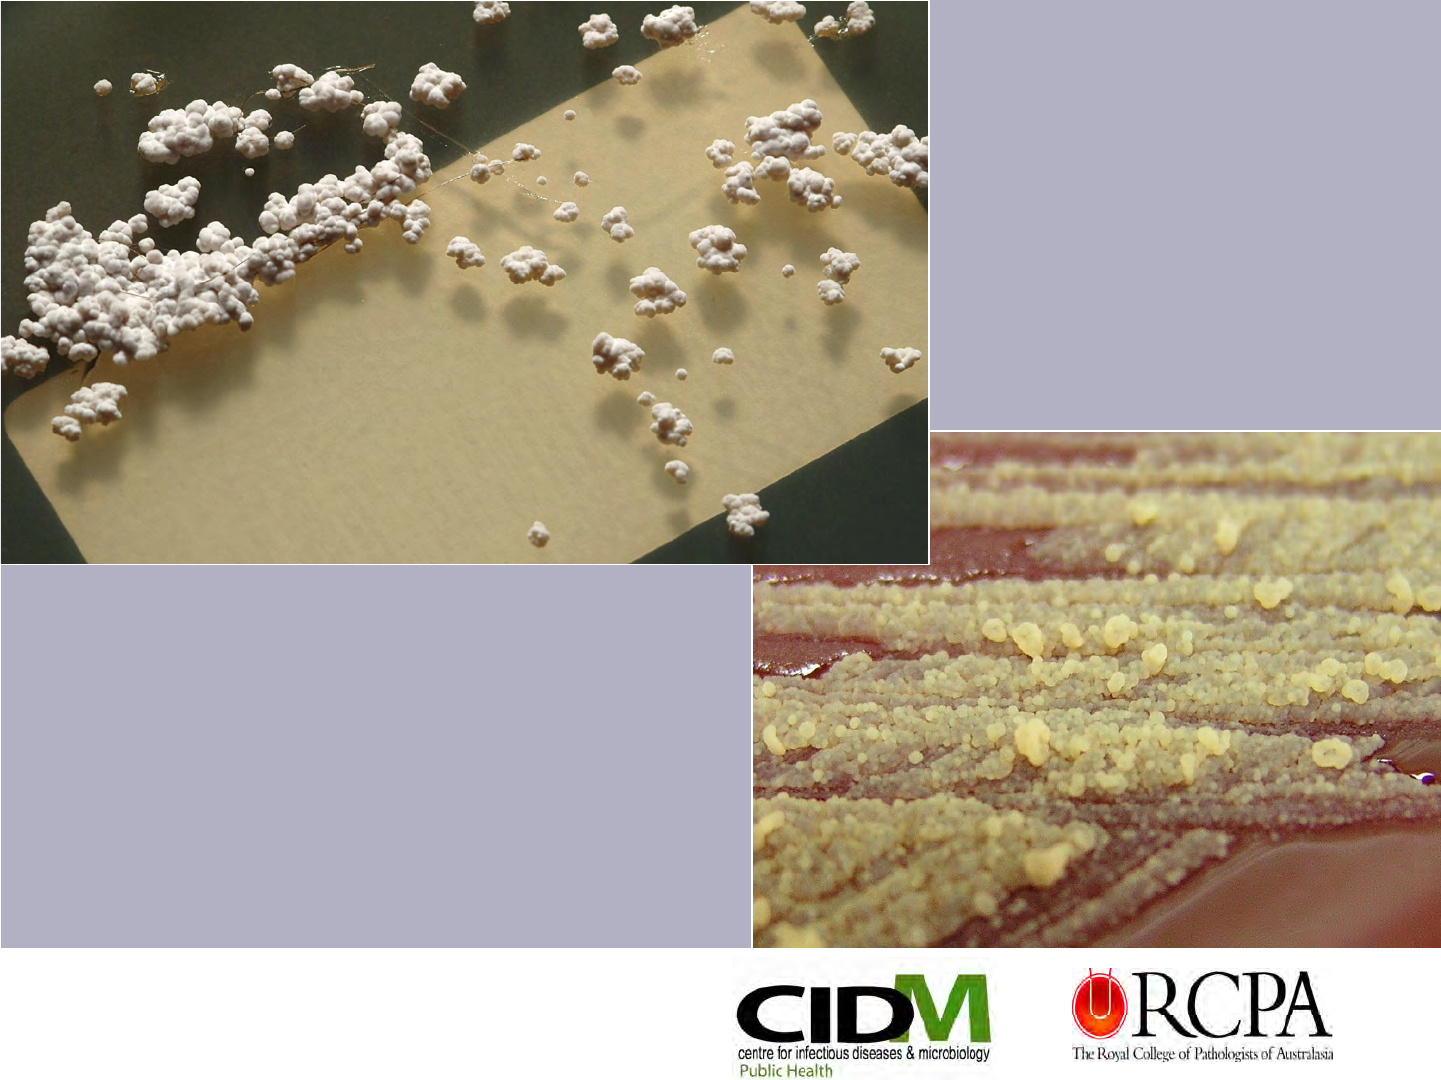
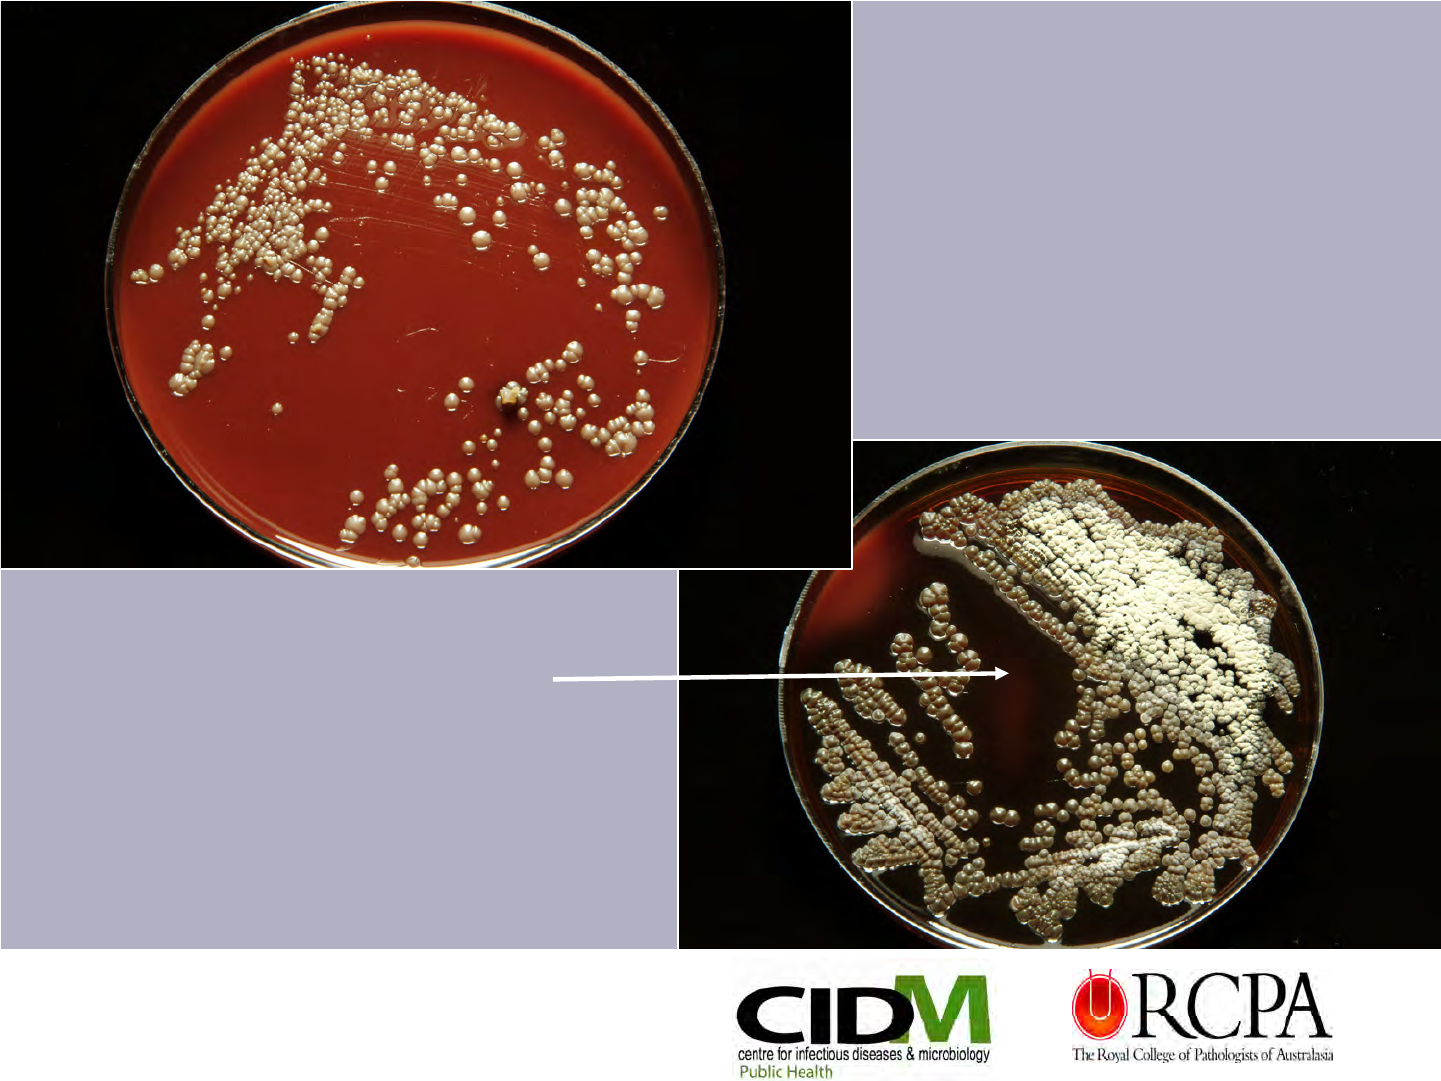
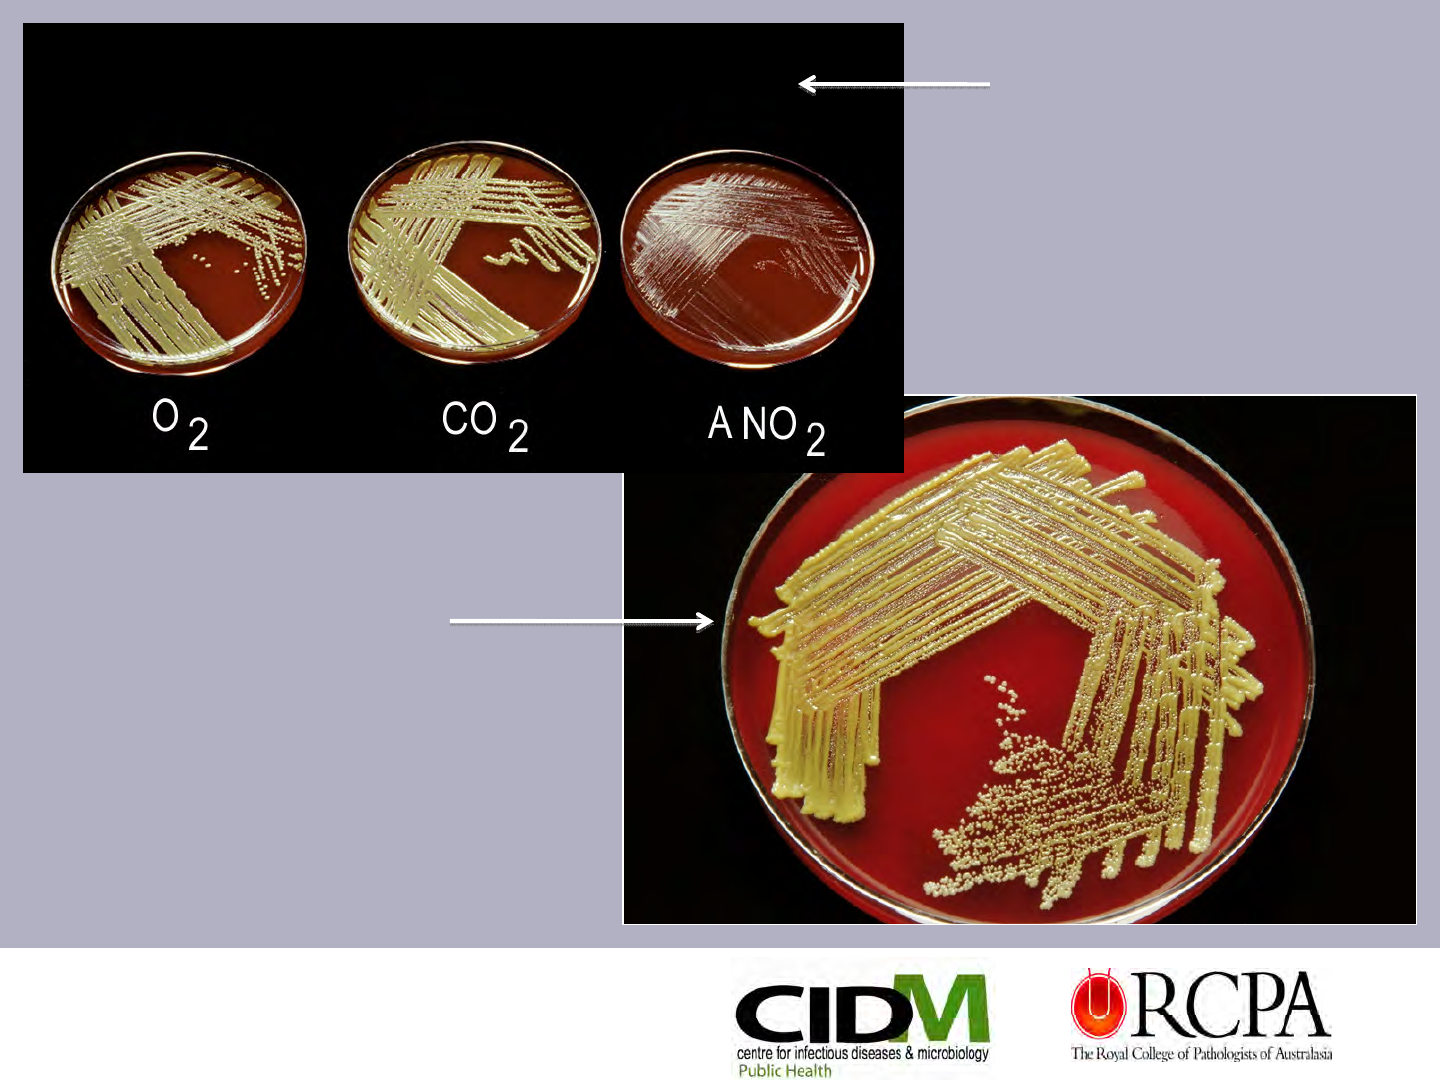
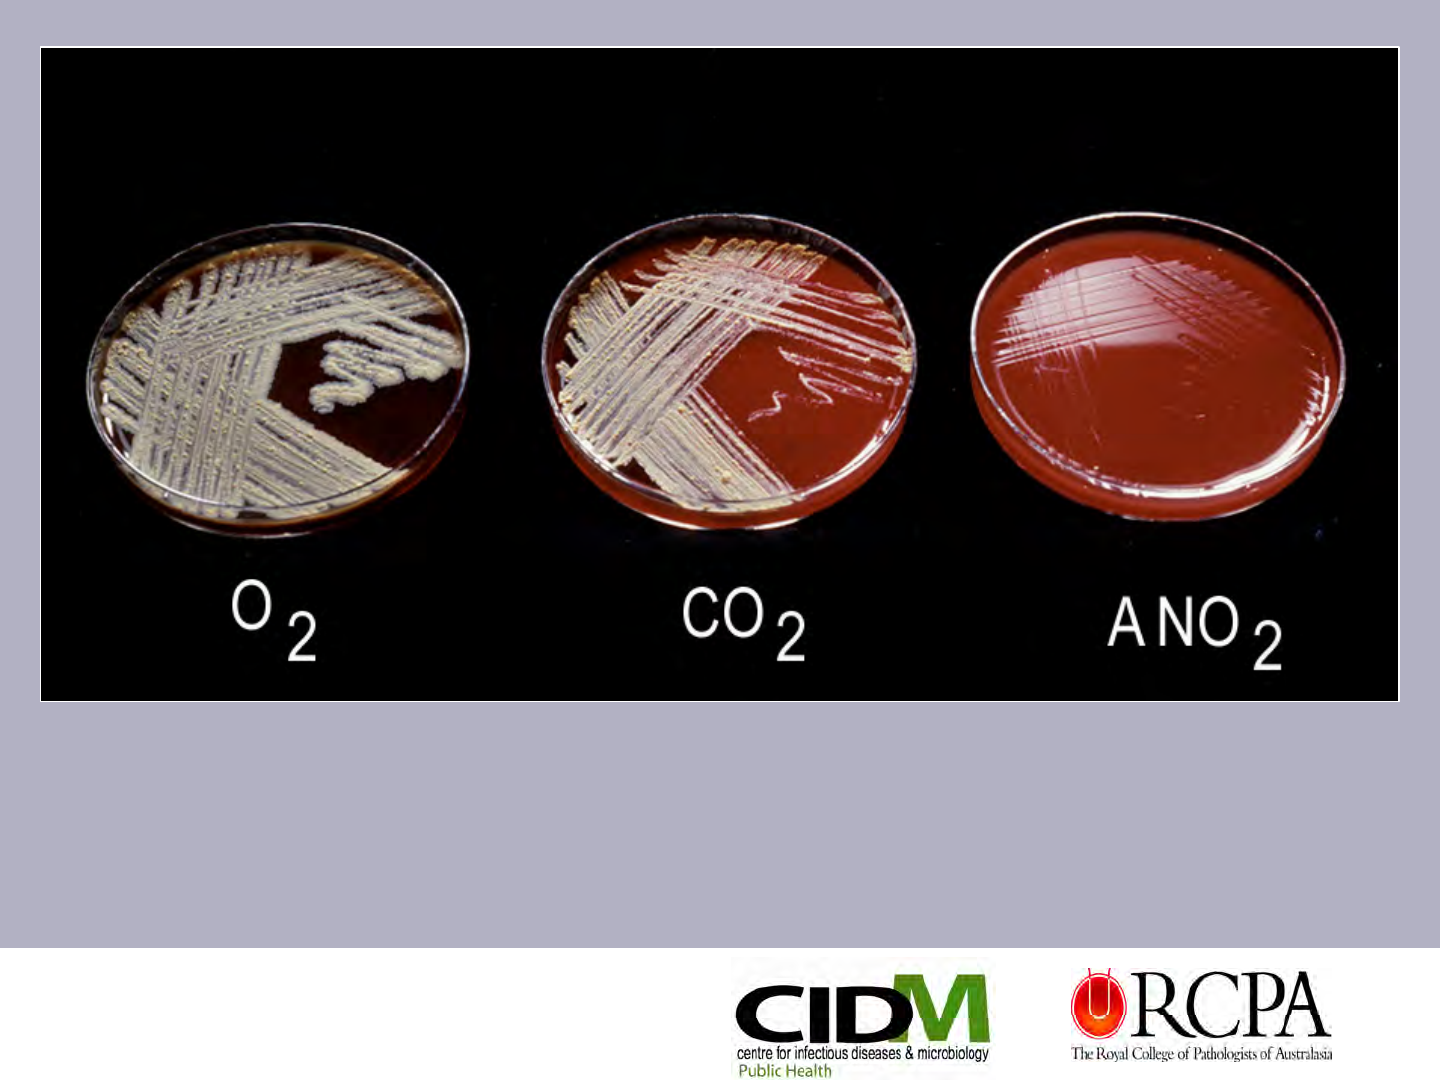
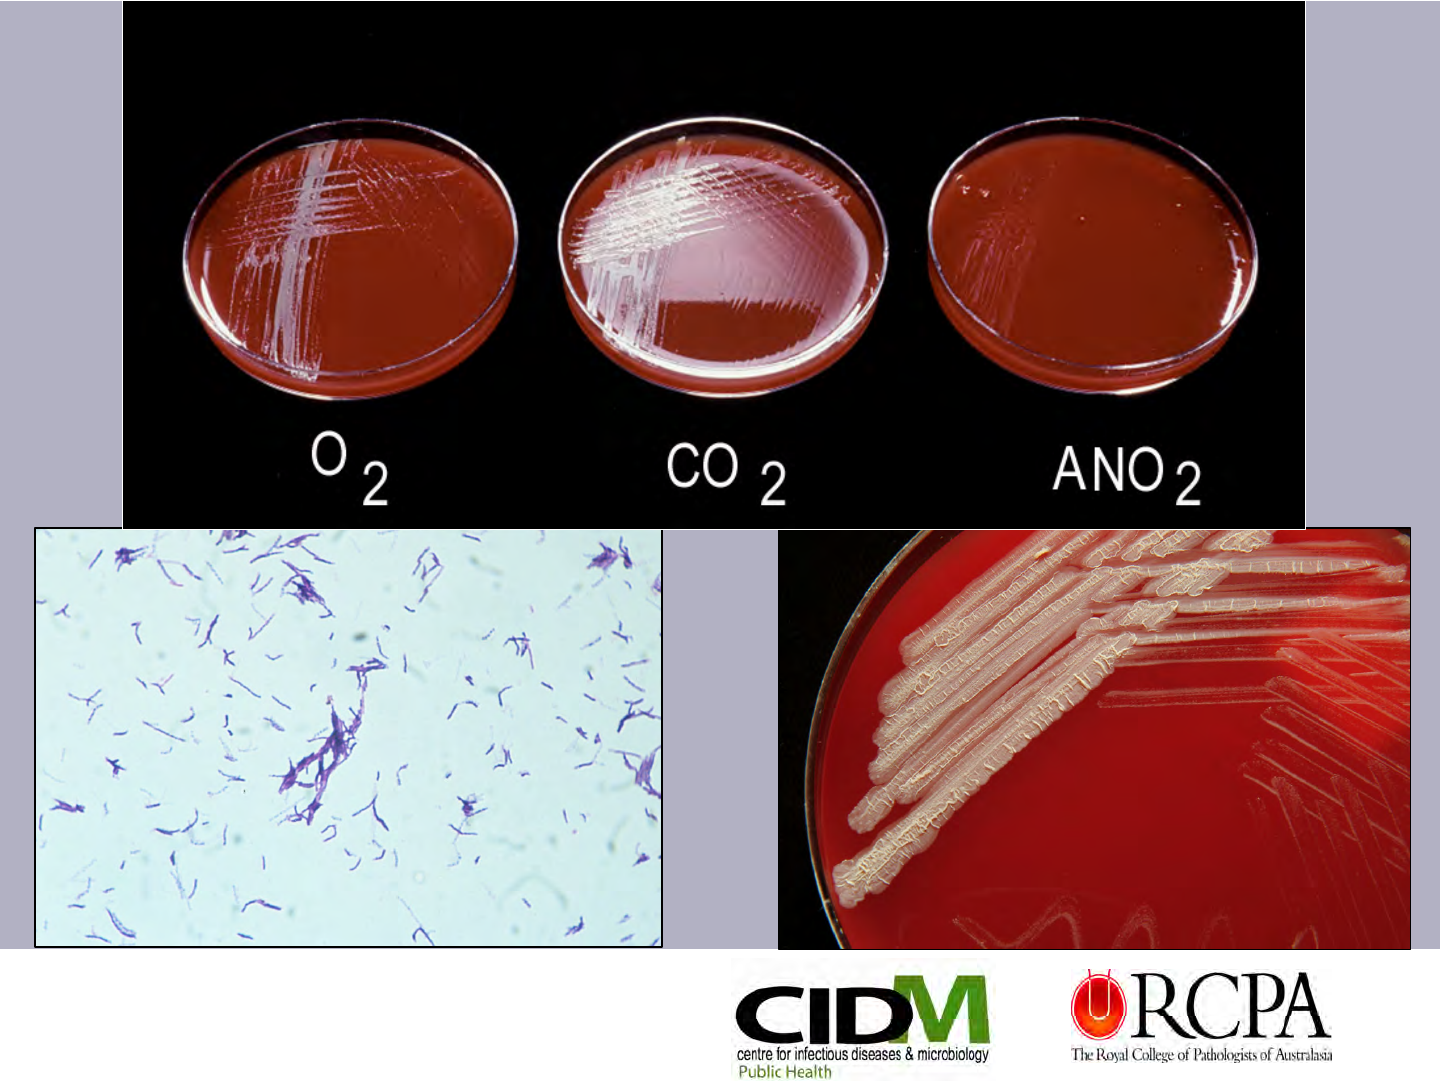
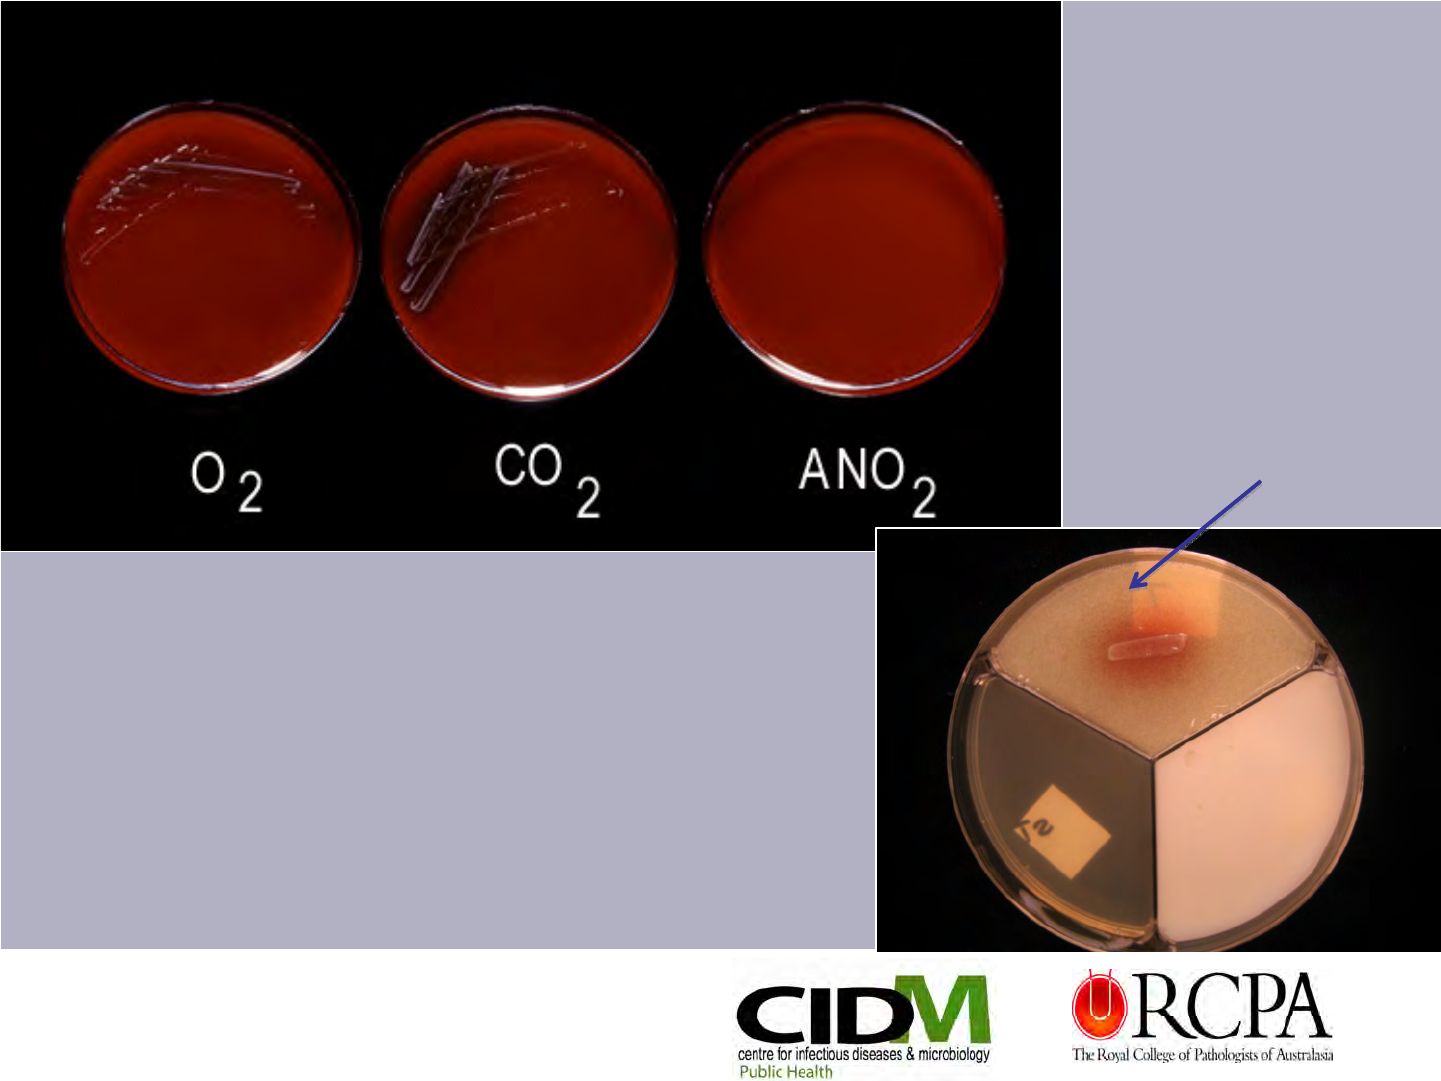
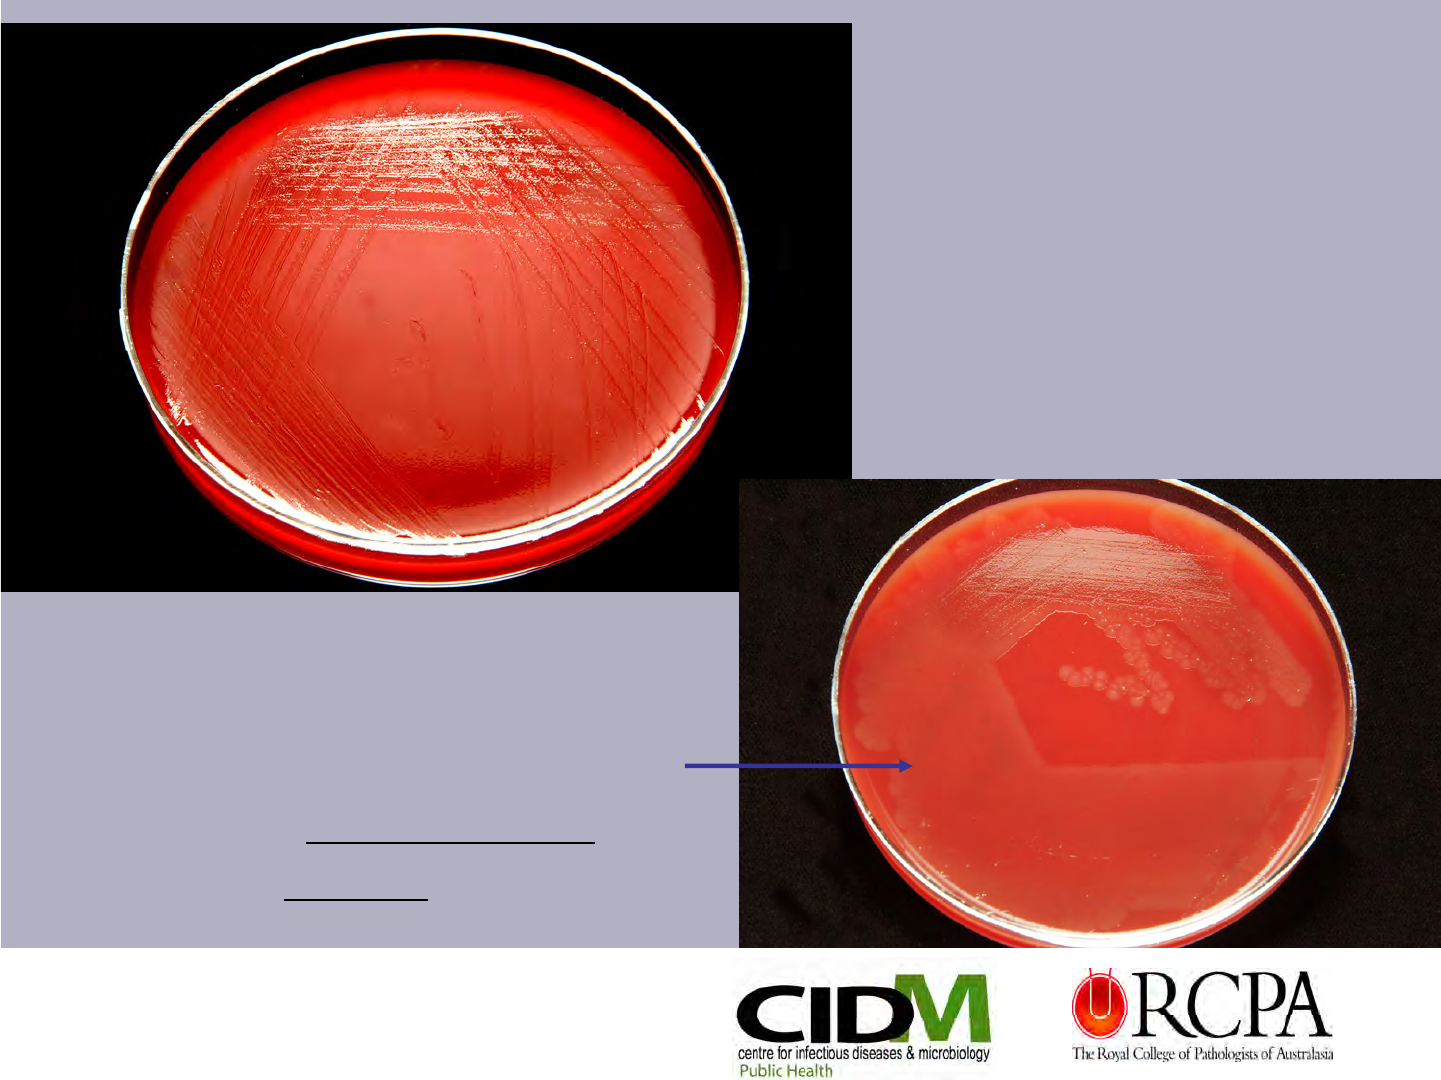
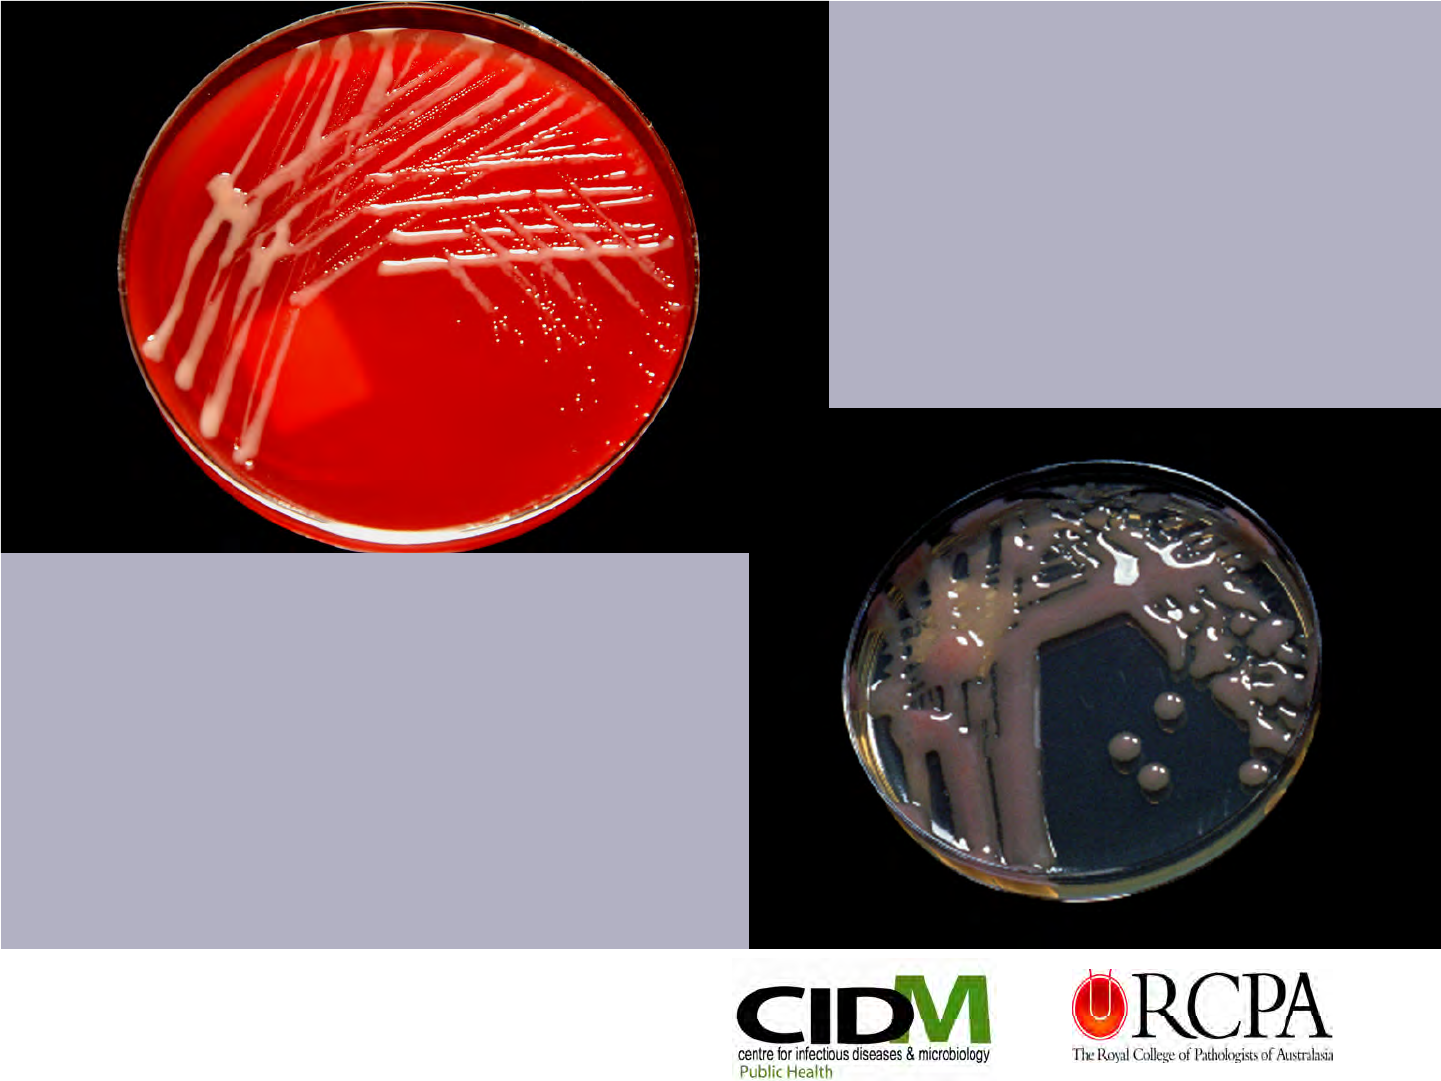
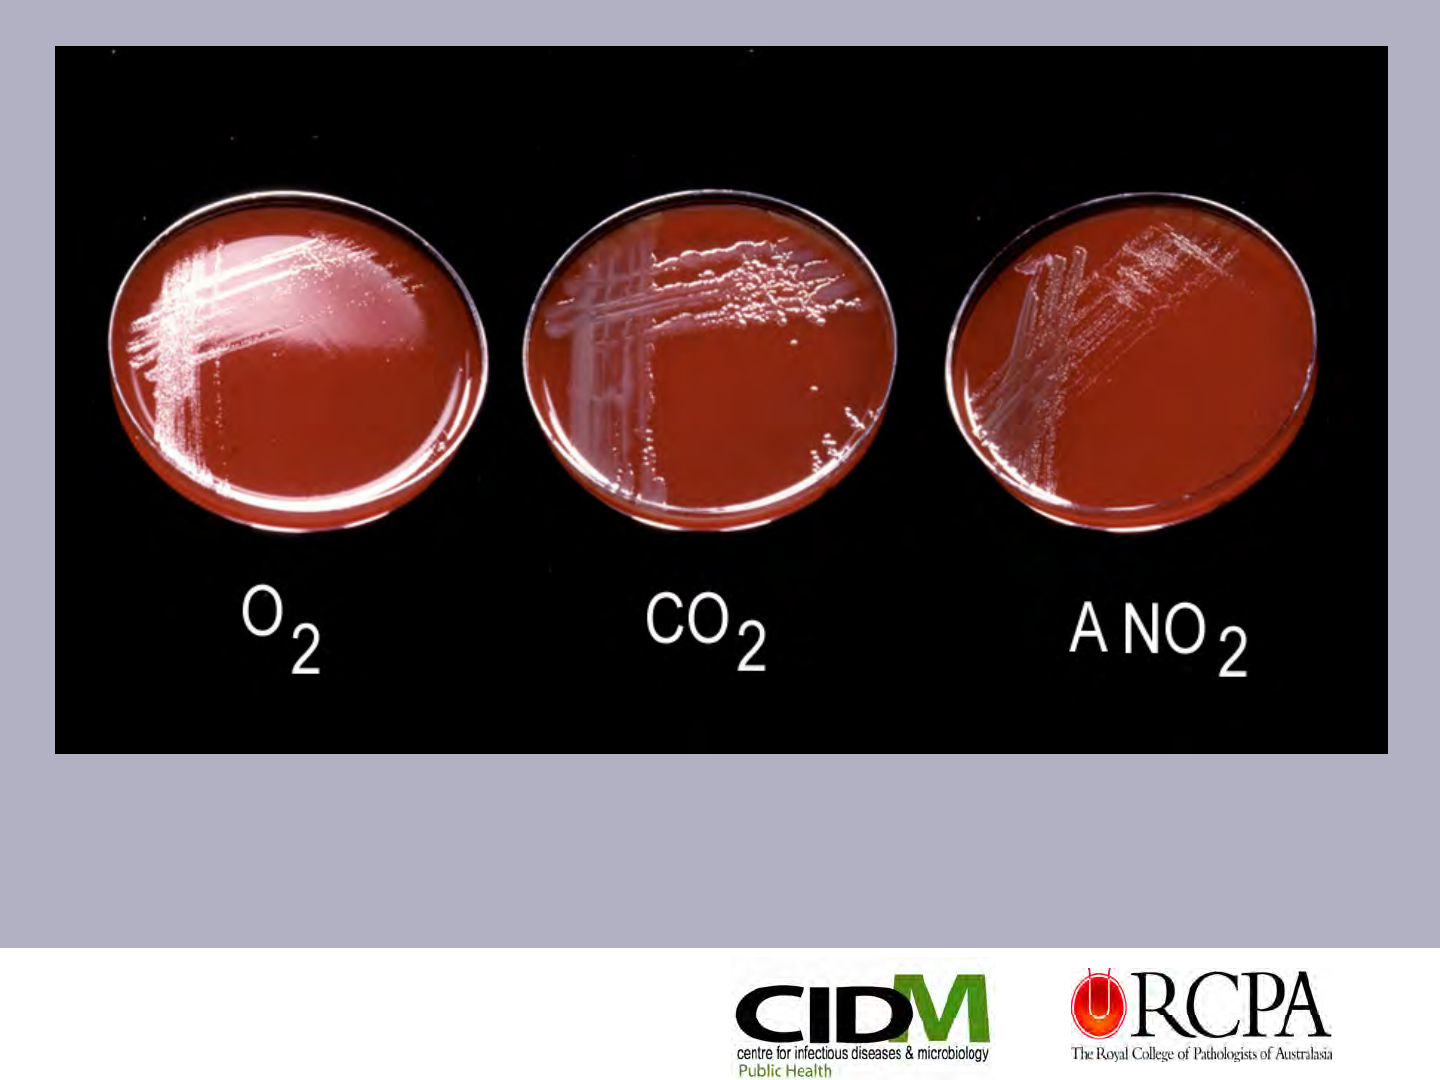
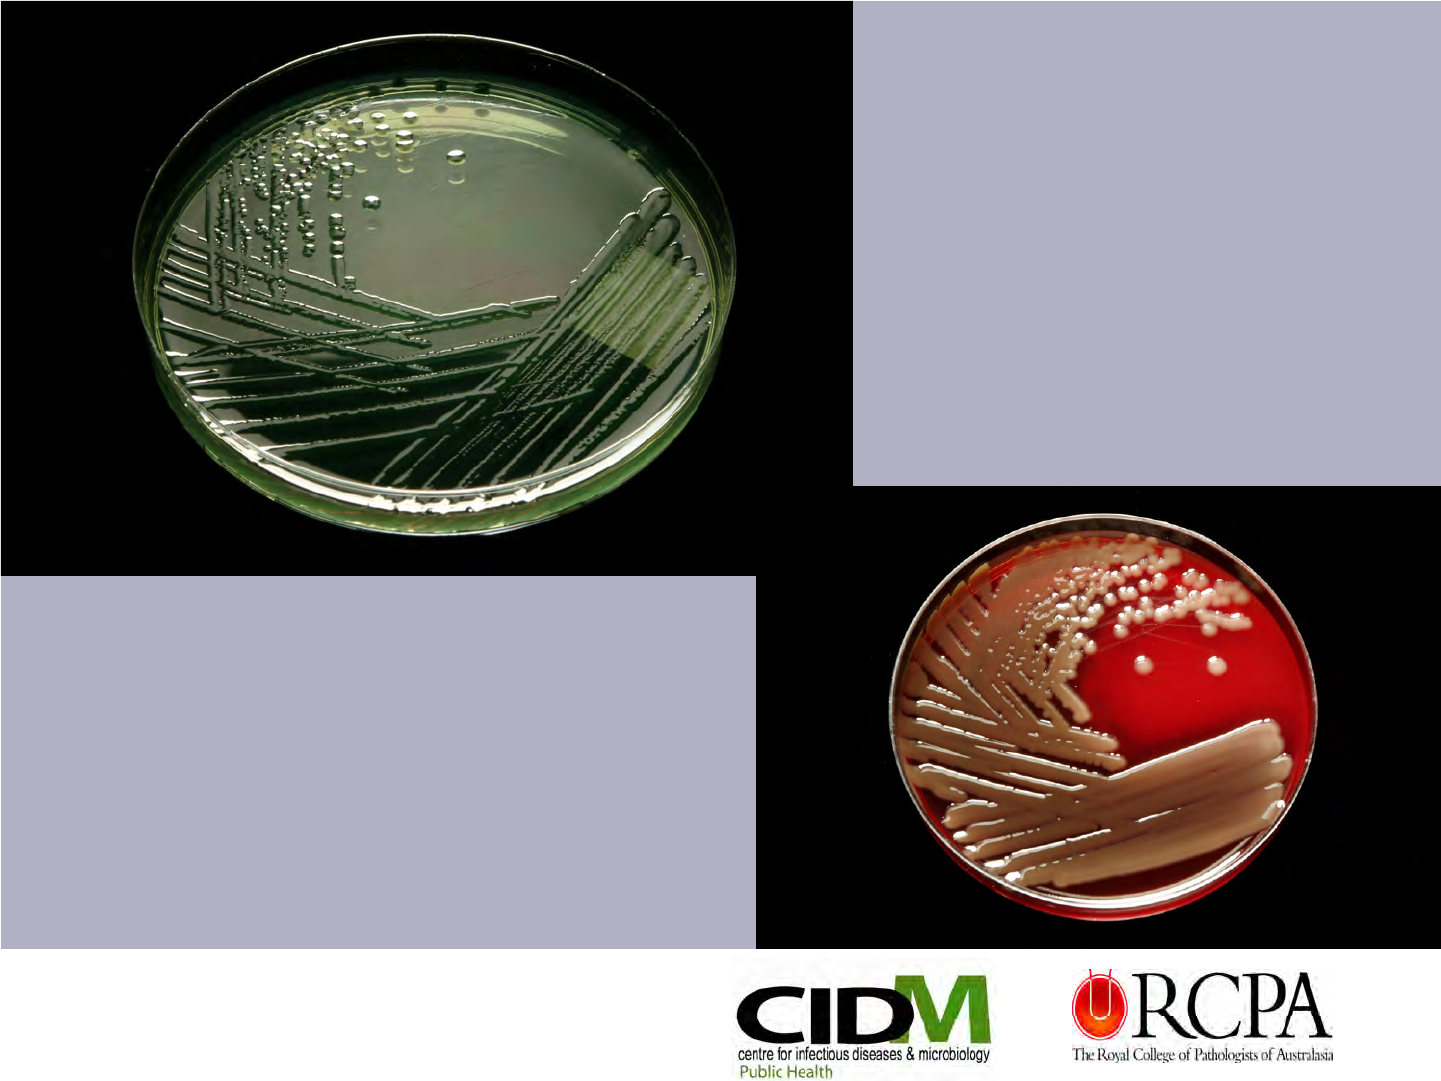
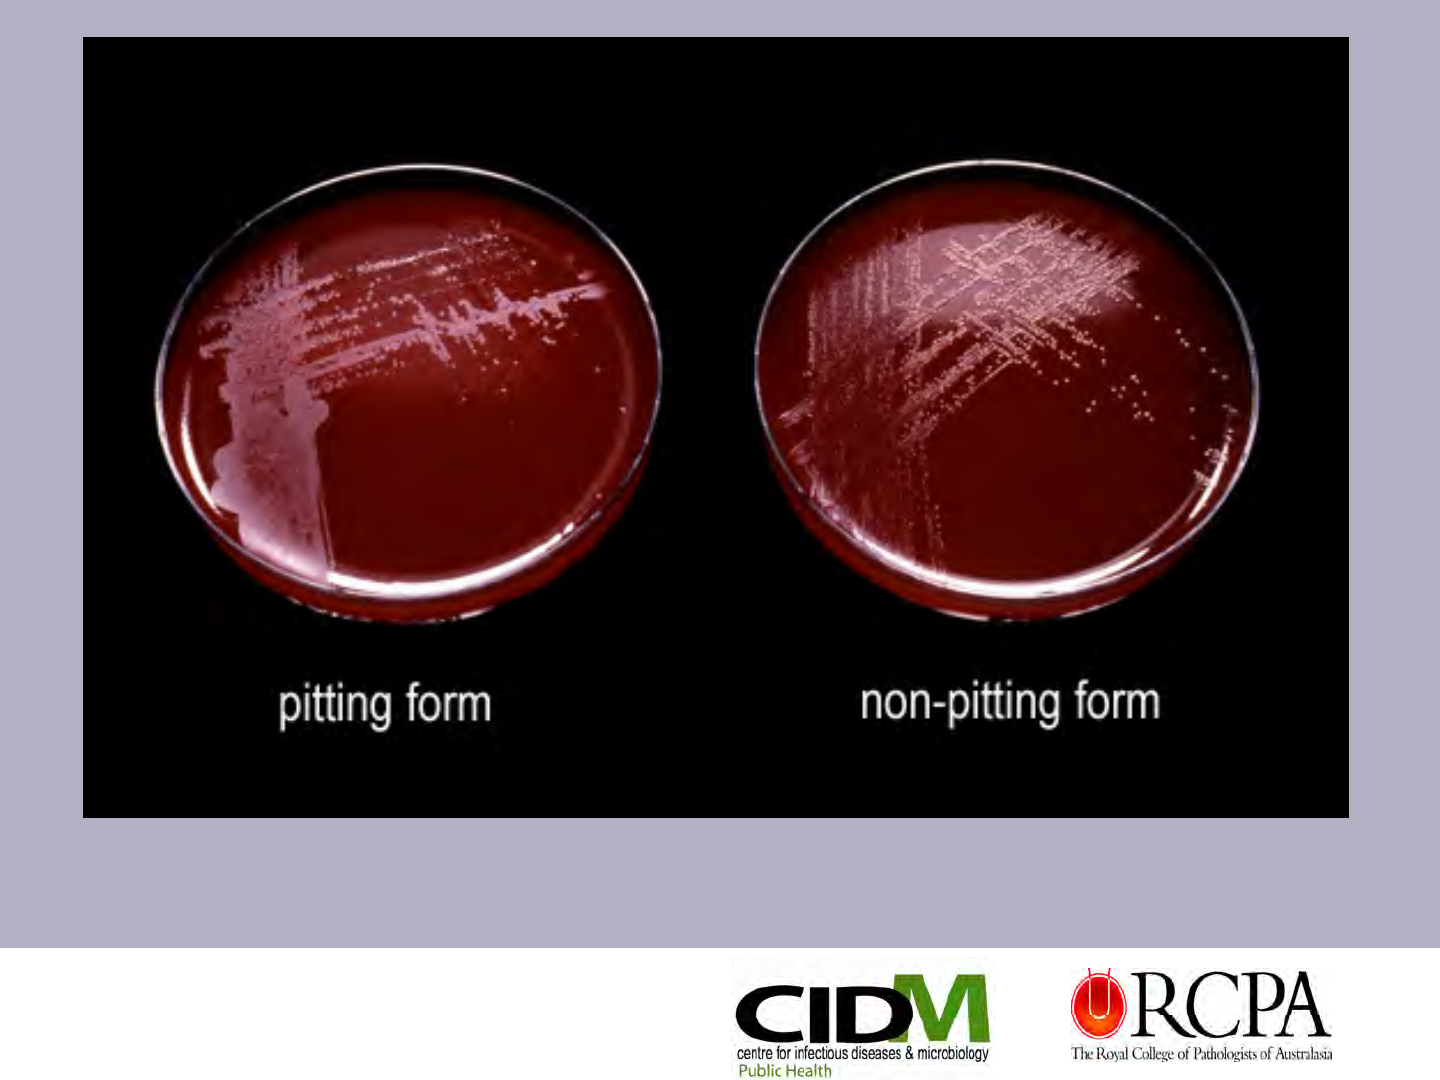
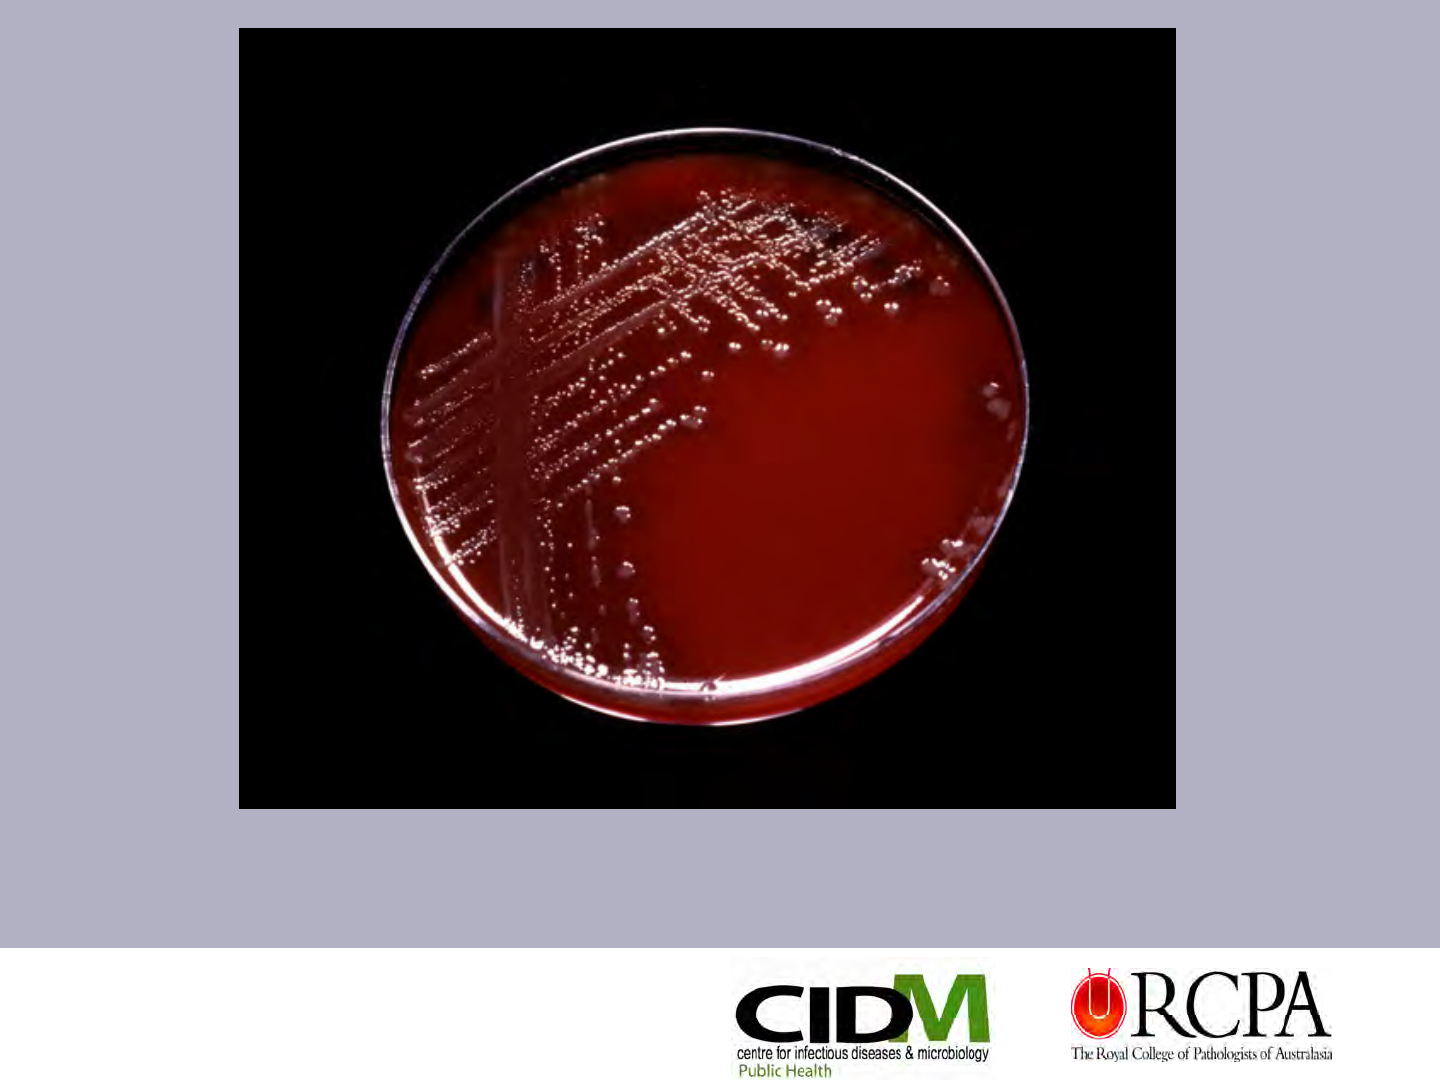
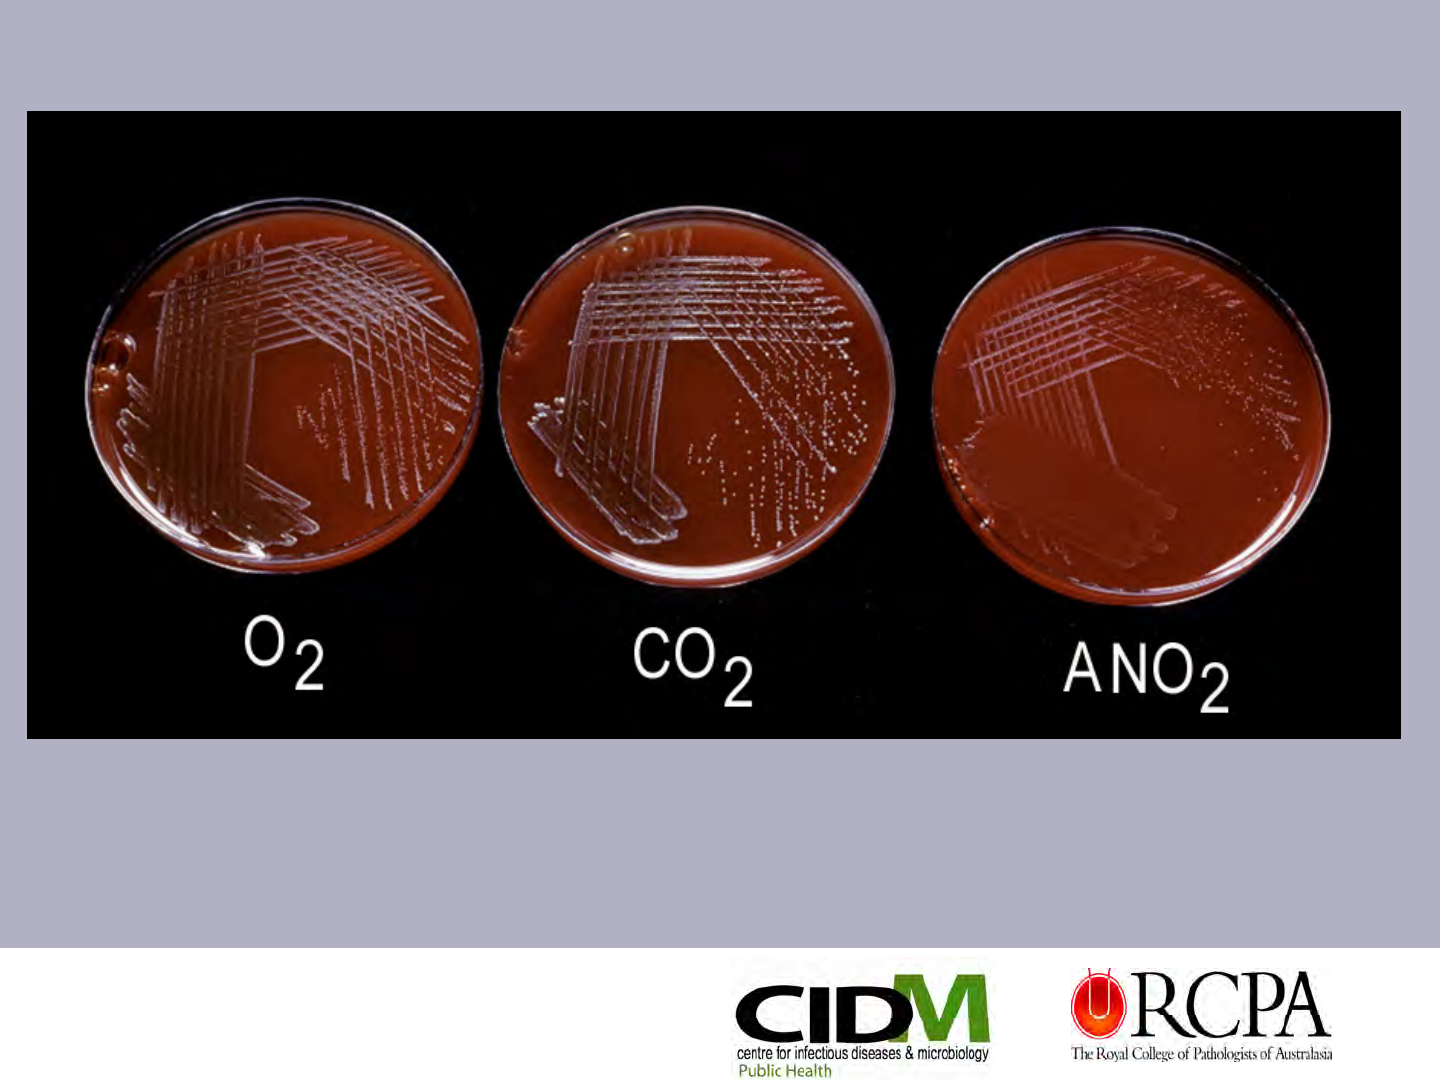
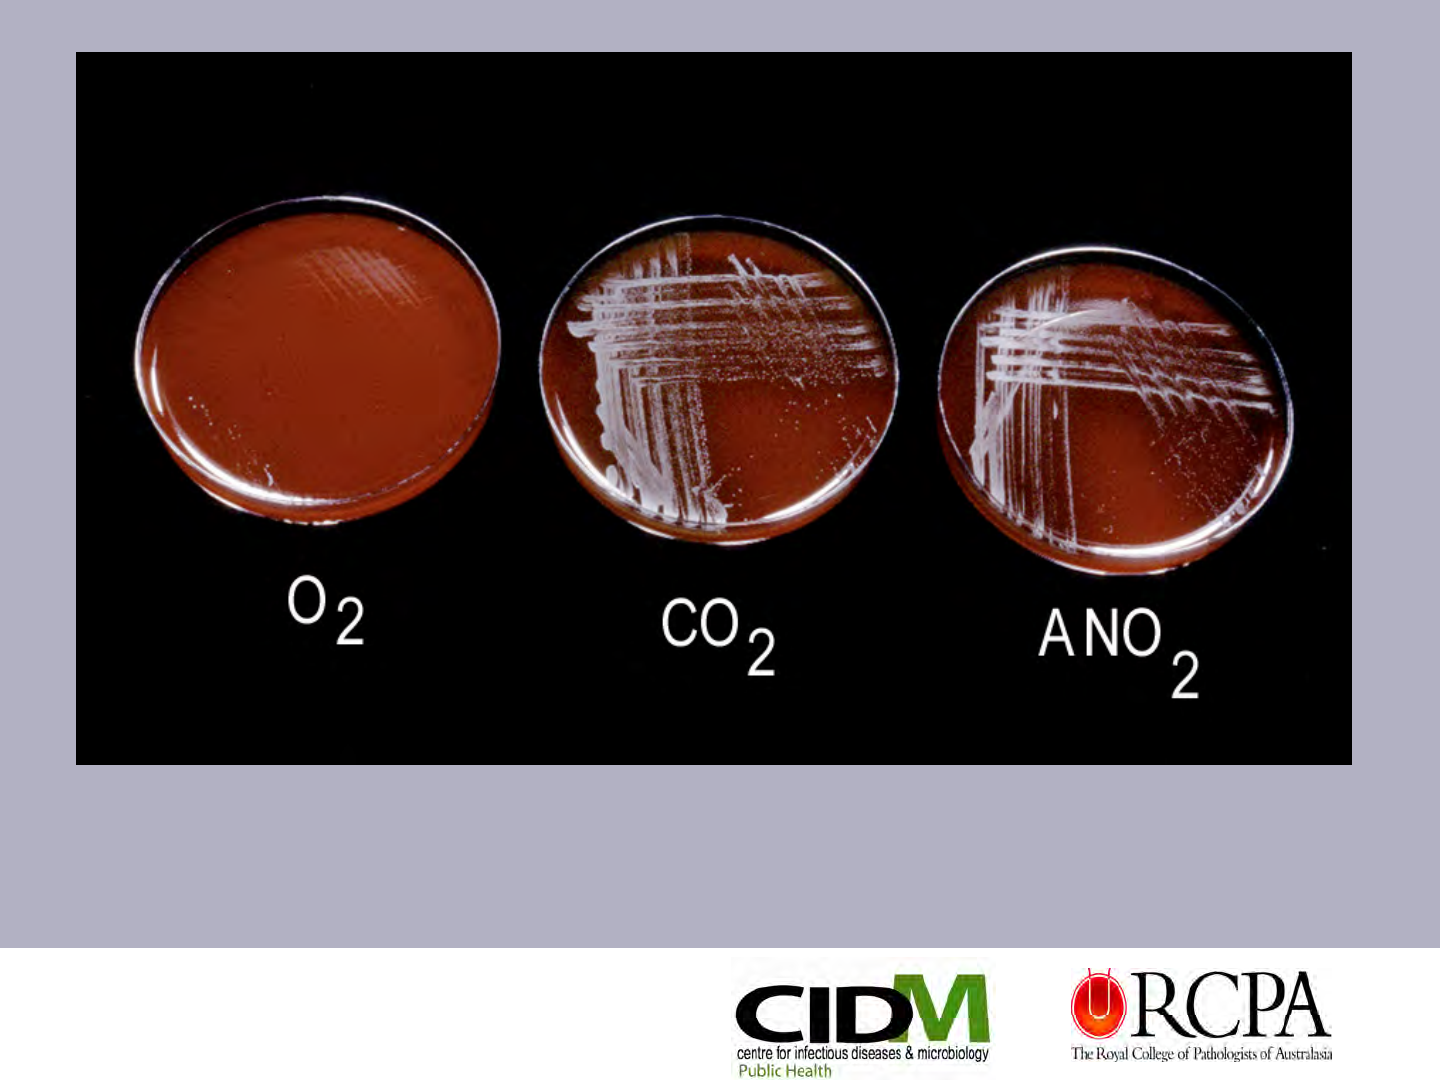

Microsoft Presentation 2 Identification Of Clinically Significant Bacteria X1000 MARIONcompressed
User Manual: X1000
Open the PDF directly: View PDF
.
Page Count: 112 [warning: Documents this large are best viewed by clicking the View PDF Link!]

Laboratory Diagnosis of Infectious Diseases:
From Basics to Molecular Methods Workshop
Friday 18 March 2011
Westmead Education & Conference Centre
Marion Yuen
Identification of Clinically
Significant Bacteria
The Royal College of Pathologists of Australasia has received
Australian Government funding under the Specialist Training Program

Streptococcus mutans
Alloiococcus otitidis
Gemella haemolysans
Helcococcus kunzii
Difficult Gram Positive Cocci
Difficult Gram Positive Cocci

Gram stain, haemolysis, motility, catalase
Morphology in BHI Broth, 24hrs @ 37 °C ?clusters or chains
Vancomycin susceptibility
Bile esculin
PYR, LAP, ADH, Aesculin, hippurate – available as
rapid disc tests (Remel, Rosco) or part of commercial kit
Growth in 6.5% NaCl, Tween 80 broths and @ 45°C
Gas from MRS broth
Tests that you need to perform

Streptococcus
Streptococcus mutans
mutans

•Text
Streptococcus mutans
gs x1000
small GPR/coccobacilli
Streptococcus mutans
grown in BHI broth
x400 phase contrast
Streptococcus mutans - HBA 24 & 48 hours

Key features
GPC regular size, in pairs, tetrads, clusters
Slow-growing (48-72hrs) due to lipid requirement
Strict aerobe and asaccharolytic (unusual for GPC)
Non-haemolytic to α-haemolytic with age
Identified by API 20 Strep & ID 32 Strep
Key tests: Catalase +/+
w
, PYR+, LAP+, 6.5% NaCl+ (slow),
45°C-, growth on BE but aesculin-, poor or no growth on CA
Alloiococcus
Alloiococcus otitidis
otitidis
Alloiococcus otitidis
gs x1000
Always check morphology
in BHI broth
(I know I go on about
this!!)
Alloiococcus otitidis
HBA @ 48hrs

Key features
Gram-variable cocci in pairs, clusters & small chains
Slow-growing
CO
2
enhances growth – G. morbillorum prefers to grow anaerobically,
G. haemolysans prefers to grow aerobically
Colonies are α-haemolytic or non-haemolytic
Growth stimulated by Tween 80
May be confused with NVS but not B6 dependent
Key tests:
PYR+/V (requires heavy inoculum), LAP (V), BE-, 45°C-,
Gemella haemolysans NO
2
+, Gemella morbillorum NO
2
-
Gemella haemolysans

Gemella haemolysans – gs x100 cocci are often decolourised

Key features
Large irregular GPC in clusters – “Aerococcus-like”
Non-haemolytic – some strains weakly α-haemolytic
Lipophilic – growth stimulated by Tween 80
Not included on all commercial kits/system databases, but
ID 32 Strep gives a profile 4100413 – “doubtful” A. viridans
Key tests to differentiate from Aerococcus: LAP-, PYR+,
aesculin+, hippurate-, NG @ 45°C, Tween 80 stimulation
Note: Follow manufacturer’s instructions for rapid disc tests
Helcococcus
Helcococcus kunzii
kunzii

Helcococcus kunzii – gs x1000 cocci are large and in clusters
Always check morphology in broth (BHI) – DO NOT RELY ON
GRAM STAIN FOR MORPHOLOGY – see next slide!

GPC’s in large clusters
prepared from HBA plate
gs x1000 -
Same organism grown in
BHI broth for 24 hrs

Helcococcus kunzii
HBA @ 24hrs
Helcococcus kunzii
HBA @ 48hrs

Difficult Gram Positive Rods

Anaerobes
Anaerobes
Clostridium tertium
Clostridium tertium
Features
Slender long Gram-positive rods with oval, terminal spores
anaerobically but not aerobically
Aerotolerant Clostridia: C. tertium, C. histolyticum,
C. Carnis
Mis-identified as lactobacillus if spores not detected or
Bacillus species if growth conditions not examined.
Key tests: Bacillus spp: cat +, sporulates aerobically
C. tertium: cat -, sporulates anaerobically

Clostridium tertium – gs x1000, terminal, oval spores

Clostridium tertium
HBA, CO
2
Clostridium tertium
HBA, ANO
2

Key features
Gram-positive rods – medium to large, some “lemon” shaped
rod forms, staining often uneven
Spores – oval, central to subterminal, distends cell
Strict anaerobe, saccharolytic
Metronidazole = S
Catalase negative
Highly motile – swarms over plate in 24hrs!
Must distinguish from C. sporogenes – lipase, lactose,
mannose, enzyme profile on Remel RapID ANA II or other
commercial kit (PRO & PYR enzymes)
Clostridium septicum

Clostridium septicum
gs x1000
central to subterminal spores,
lemon-shaped cells
Swarming over HBA
plate in 24 hrs

Bifidobacterium longum
Special features
Habitat intestinal tract of man and animals
Anaerobic GPR - some species are aerotolerant
Curved rods, rudimentary branching and “bifid” forms, dog
bone, long club forms - Gram stain morphology is the key!
Generally resistant to MTZ
Fermentative
>30 species – B. dentium (
previously B. eriksonii only pathogen)

“Bifid” form
Bifidobacterium spp.
gs x1000
Bifidobacterium spp.
some species are
aerotolerant
Check growth conditions!

Cardiobacterium hominis - HBA @ 48hrs
Dermabacter hominis
Key Features
GPR – small coccoid to tear drop shaped coryneform rods
Colonies white to grey, shiny, can be sticky
Fermentative metabolism
Identifies on API Coryne
Unusual reactions: LDC +, ODC +, aesculin +

Dermabacter hominis
Dermabacter hominis
48hrs HBA
Dermabacter
hominis
gs x1000

Actinomyces species
GPR, coryneform, curved, irregular, some branching or extensive branching
Note: Some newer Actinomyces spp. show very little branching and may appear
coryneform
Colony appearance varies with species
Non-haemolytic, α-haemolytic or β-haemolytic
Hints that an isolate may be an Actinomyces are:
-fermentation of xylose, lactose or aesculin hydrolysis
-growth conditions
API Coryne ID: Microbacterium/Cellulomonas, G. vaginalis

Actinomyces
turicensis
gs x1000
Actinomyces turicensis
Close-up
Actinomyces
turicensis
24 & 48hr HBA

Actinomyces israelii – gs x1000 – microcolony grown in BHI broth
Actinomyces neuii spp. neuii
gs x1000
Note – irregular GPR, curved
rods with tapered ends
Actinomyces odontolyticus
Note – anvil shaped rod & small
rudimentary branch node
Actinomyces spp. vary in their Gram stain appearance

Corynebacterium sundsvallense
Special features
GPR - irregular pleomorphic rods
Catalase +
Fermentative
Non-haemolytic
Non-pigmented
Non-motile
No substrate or aerial mycelium
Colonies resemble aerobic actinomycete but growth
conditions are consistent with Corynebacterium

C. Sundsvallense
gs x1000
showing swellings
at end of rods
C. Matruchotii
gs x1000 - whip handles
Corynebacterium sundsvallense – HBA, 72hrs
C. durum, C. matruchotii &Rothia dentocariosa share similar characteristics

Key features
Gram-positive coryneform & irregular, curved rods
Colonies 0.5mm smooth, dry, whitish colonies at 24hrs
β-haemolytic colonies best observed @ 48hrs
3 medically relevant species: A. haemolyticum, A. pyogenes,
A. bernardiae
Identifies well on API Coryne
key tests to differentiate species - gelatin, xylose, glycogen
Arcanobacterium haemolyticum

A. haemolyticum – gs x1000 irregular gram positive rods
Arcanobacterium haemolyticum - showing β-haemolysis at 48hrs

Microbacterium oxydans
Key features
GPR regular or pleomorphic, curved
Colonies moist white-cream or yellow with age
Motile or non-motile
Oxidative metabolism but genus is a mixture of both
oxidative & fermentative species – makes ID confusing
API Coryne usually gives a clue (mannitol +, Aesc +) but
check growth conditions

Microbacterium spp. -gs x1000
Microbacterium spp.
HBA @ 48hrs
pigment varies from white,
grey to yellow

41
Aerobic Actinomycetes
Before
Before we get started
we get started -
-
Questions you need to answer
Questions you need to answer
Is the isolate a strict aerobe (oxidative) or facultative
anaerobe (fermentative)
Is the organism a GP branching rod or irregular non-
branching rods
Do the rods stain poorly
Is there a substrate mycelium and aerial hyphae
Is there substrate mycelium only
Is there neither substrate nor aerial hyphae
Is the isolate acid fast by ZN or modified ZN

First
First -
-Why are some bugs
Why are some bugs
acid fast?
acid fast?
Cells that are acid fast contain mycolic acids
(large group of long chain fatty acids of varying length)
The amount of mycolic acids will confer varying degrees of
resistance to chemicals, permeability & acid fastness (stain
binds to cell wall mycolic acids)
Mycolic acid chain length (carbon number)
0 20 30 40 50 60 70 80 90
Coryne Dietzia Nocardia Tsukamurella Mycobacterium
Rhodococcus
Gordonia

Are you sure you know what
Are you sure you know what
you
you’
’re looking for and
re looking for and
how to go about it?
how to go about it?
Secondly – Aerial hyphae &
substrate mycelium

Looking for Substrate and Aerial
Looking for Substrate and Aerial
Hyphae
Hyphae?
?
Place culture plate on stage - must
use clear medium e.g. NA, MHA, SAB
Drop condenser to increase contrast
Start with x10 objective to locate
individual colonies
Change to x20 objective to examine
structures more closely, BUT don’t end
up in the agar!

Rhodococcus equi
Special features
GP rods – coryneform, jointed or rudimentary branching –
morphology varies according to progression of the rod-coccus cycle
Non-motile
Oxidative metabolism
Colonies – translucent mucoid, salmon pink with age
Marked rod-coccus cycle but no substrate or aerial hyphae
May be partially acid fast (Modified ZN)
Identifies on API Coryne
Note: mucoid pink colonies could be Roseomonas spp. or other pink
oxidative GNR – check gram & do vancomycin or string test

Rhodococcus equi
rod-coccus cycle - note
variation in morphology
Jointed rods

Rhococcus equi – showing oxidative growth pattern
No substrate or aerial hyphae
Compare this image to the
next slide

Nocardia spp. – x400
Early colony development showing substrate mycelium

Nocardia spp. NA x10 - note substrate & aerial hyphae
Dark aerial hyphae
Light substrate mycelium

Don
Don’
’t be tempted to look for
t be tempted to look for
substrate mycelium or
substrate mycelium or
aerial hyphae too soon!
aerial hyphae too soon!
Check out the next slide
Check out the next slide ……
…….
.
Important Note
Important Note

Corynebacterium sundsvallense – MHA, 4 days, x100

Nocardia
Nocardia species
species
Key features
GP beaded branching rods, fragment to non-motile rods coccobacilli
Colonies adherent, dry, chalky, heaped & folded with age
Strict aerobe
Acid-fast - modified ZN stain (Kinyoun)
Substrate mycelium & aerial hyphae
Key tests: Lysozyme = R, speciate by antibiotic susceptibility,
assimilation reactions, amino acid hydrolysis reactions &
Arylsulfatase test - (+ for N. nova only)

Complex “birch tree” branching
Nocardia spp. - NA x100

Nocardia spp.
branching GPR
branches are often at
right angles
Nocardia spp.
gs x1000
Fragmentation to rods
& coccoid elements

Nocardia spp. – Modified ZN stain
showing partial acid fast coccoid-rod elements
Nocardia spp.
NA slope @ 7 days
Pigment varies from
chalk white, salmon
pink, orange
Colonies are adherent, dry,
heaped and folded with
earthy odour

57
Streptomyces
Streptomyces species
species
Key features
Long filamentous gram positive filaments with minimal branching
Colonies khaki grey, heaped, folded, adherent, become chalky
white with age, earthy odour
Strict aerobe
NOT acid-fast
Substrate mycelium, occ. aerial hyphae that form chains of conidia
No Fragmentation occur
Lysozyme = S, biochemically difficult to speciate – perform16SrRNA
gene sequencing

Streptomyces griseus, x100 - MHA at 48-72 hours

Streptomyces spp.
gs x1000
Long filamentous hyphae
with less branching than
Nocardia spp.
Streptomyces spp.
24 & 48hr, HBA
Colonies become dry &
chalky white as aerial
hyphae form

Oerskovia
Oerskovia species
species
Key features
Irregular GPR, branching filaments
Colonies - smooth, glistening, bright yellow
Facultative anaerobe, Fermentative
NOT acid fast
Substrate mycelium that fragments into motile elements but NO
aerial hyphae.
This differentiates L. aquatica and Microbacterium from Oerskovia
API Coryne identifies Oerskovia
Key tests: hydrolysis of casein, gelatin, xanthine, hypoxanthine

Substrate mycelium,
no aerial hyphae
Oerskovia spp. - NA, x1000, Substrate mycelium only
Bright yellow pigment
2 species –
Oerskovia turbata
Cellulosimicrobium xanthinolytica
Oerskovia spp.
Facultative anaerobe
Excludes Leifsonia
aquatica

Tsukamurella
Tsukamurella species
species
Key features
Irregular GPR – no obvious branching, may stain
gram variable
Rough & highly wrinkled colonies in 1-2 days
Pigment varies with species – wh, cr, yell, orange
Aerobic
Partially & weakly acid fast by ZN & Modified ZN
No substrate or aerial hyphae
Lysozyme = R, 3 Day Arylsulfatase test –, Urea +

Tsukamurella spp. – gs x1000
Tsukamurella inchonensis - HBA @ 72hrs
Oxidative metabolism – no growth ANO
2

Tsukamurella spp.
Whole colonies - NA plate at 4
days “spider-like” colonies

Tsukamurella colonies, NA plate at 7 days – closer view
This is not substrate or aerial hyphae! – only sticky rods

Mycobacterium
Mycobacterium fortuitum
fortuitum
Mycobacterium abscessus
Mycobacterium abscessus
Key features
Faint staining, gram-variable filaments & curved rods, “ghost” cells
(branching filaments can occur with M. fortuitum)
Slow-growing (3-5 days) aerobe
Colonies non-pigmented, buff to yellow, smooth or dry
Acid-fast but may be weak or partial
Members of M. chelonae complex – highly resistant to antimicrobial
therapy
Close up – colonies can be dry or moist

Mycobacterium fortuitum – 3 months on NA
Simple “fir tree” type mycelium

Cardiobacterium hominis - HBA @ 48hrs
Let
’
s have a break and take in the view!

Gram Negative Rods

74
Bordetella
Bordetella holmesii
holmesii
Key features
Small to medium slender GNR, some curved rods
Non-haemolytic, slow growing aerobe
Oxidase -, Catalase V, MAC + but growth is slow
Oxidative
Non-motile
Non-reactive - browning on tyrosine agar
Not on database of commercial ID kits/systems

Bordetella holmesii
gs x1000
small-medium slender GNR
some curved
mis-identifies as
Acinetobacter spp.
BUT Gram stain morphology is not
plump GNCB!
Bordetella holmesii
growth O
2
& CO
2
but not anaerobic
typical of oxidative organisms
Browning on
Tyrosine agar

Moraxella atlantae
Key features
Plump GNCB, often stains gram variable
Strict aerobe - Oxidative
Growth stimulated by bile salts (MAC growth is better or equal to HBA)
Non-motile buy twitching has been observed (pili)
OX+ (excludes Acinetobacter spp.), CAT+, asaccharolytic
M. osloensis – some strains tributyrin +, ß-Lactamase +, vancomycin, R

Moraxella atlantae
gs x1000
Plump GNCB
Cells can stain Gram variable & are
very coccoid – always check with
penicillin challenge & String Test
79
Moraxella atlantae @ 4 days
showing spreading flat
growth
Important feature is the
colony appearance
Colonies are clear & tiny @
24hrs, pitting and non-pitting
forms do occur

80
Roseomonas gilardii
Key features
Plump coccoid to oval rods in pairs or short chains
Resists decolourising
Colonies mucoid and pale rose pink
Most species grow on a broad range of media & at 30-42°C
Oxidase +w/-, Urease +
Roseomonas spp. are not on database of API 20 NE - identify
as Methylobacterium spp.
Confused with N. gonorrhoeae - grows on TM medium

Roseomonas spp. – gs x1000
82
NA plate showing mucoid
colonies with pale rose
pigment
Roseomonas cervicalis
HBA, 48hours

HBA, 37°C at 5 days SAB & HBA, 30°C at 5days
Methylobacterium spp.

84
Methylobacterium spp. - gs x1000
Terrible gram – but this is what it can look like!

Capnocytophaga ochracea
Key features
Slender, fusiform rod, tapered ends
Capnophilic
Gliding motility
Yellow-orange “ear wax” pigment (swab technique)and pink-lilac sheen
Colonies fringed to spreading, beaten copper look (C. ochracea)
Bluish-grey, entire colonies (C. canimorsus)
Key distinguishing tests: OX, CAT, ADH

Capnocytophaga ochracea
gs x 1000
Spreading growth, beaten
surface of colonies
Capnocytophaga ochracea
HBA @ 48hours

Key features
One of two agents of Rat-bite fever (also Spirillum minus – Sodoku)
Recovered occasionally from blood culture with no added SPS
Check patient history - ?rat bite, pet rat, drug abuse
Unusual Gram stain – ‘string of pearls’, chains, filaments, swellings
Non-haemolytic to weak alpha with age
Non-motile
Fermentative metabolism
Identification – use a rapid substrate method e.g. ID 32 STREP or similar
Streptobacillus moniliformis

Streptobacillus
moniliformis
gs x1000
filamentous GNR
with swellings

90
Vibrio vulnificus
Special features
Cause of wound infections & primary septicaemia following ingestion of
oysters
Curved & straight GNR
OX+/Fermenter
Growth on TCBS = green
Key tests: O/129 = S
Salt tolerance to 6% (65%)
Fermentation of sucrose -, salicin +, cellobiose +, lactose + >75%
Vibrio vulnificus
Green colonies on TCBS
at 24 hrs
Vibrio vulnificus
colonies on HBA at 24 hrs

92
Vibrio vulnificus – Salt Tolerance

Vibrio parahaemolyticus
Special features
Cause of acute GE – consumption of contaminated seafood worldwide
Curved GNR
OX+/Fermenter
TCBS = green
Key tests: O/129 = S/R, salt tolerance to 8% (most strains),
fermentation of sucrose -, salicin -, lactose -, cellobiose -, urea +
(50% of strains)

The
The “
“HACEK
HACEK”
”Group
Group
What defines this group of organisms?
Gram stain morphology
Cultural characteristics – e.g. β-haemolysis i.e. K. kingae, pitting
colonies, no growth on MAC, colony appearance i.e. dry, adherent,
mixed appearance, slow growth rate
Initial requirement for CO
2
and X factor (lost on subculture)
Key biochemical characteristics – e.g. indole (C. hominis)
Best identified using a rapid substrate method

95
Cardiobacterium
Cardiobacterium hominis
hominis
Key features
Faintly stained Gram-negative regular rods
“Comets” and rosette arrangements
Colonies whitish, shiny, may pit the agar
Key test: Fermentative, oxidase + cat -, indole +
Differentiate from indole + Suttonella (Kingella) indologenes

Cardiobacterium hominis
gs x1000
note ‘comet tails’

97
Cardiobacterium hominis - HBA @ 48hrs
Eikenella corrodens
Key features
Faintly stained slender, straight sided, very regular
gram-negative rods
May be X-dependent on isolation (ignore this)
OX +, CAT -
Pitting and non-pitting colony forms
Key tests: Asaccharolytic, NO
3
+, ODC +, LDC +

98
Eikenella corrodens - gs x1000
Eikenella corrodens - HBA CO
2
@ 48hrs

100
Cardiobacterium hominis - HBA @ 48hrs
Kingella kingae
Key features
Plump Gram-negative coccobacilli in pairs & short
chains, parallel rows & “railway tracks”
“Soft” β-haemolysis on HBA
Acid from glucose & maltose – has been confuse with
N. meningitidis
Associated with bone and joint disease in children

Cardiobacterium hominis - HBA @ 48hrs
Kingella kingae
gs x1000
Magnified view
Cardiobacterium hominis - HBA @ 48hrs
Kingella kingae, HBA, CO
2
at 48hrs

Aggregatibacter
Aggregatibacter aphrophilus
aphrophilus
Key features
Small Gram negative coccobacilli
Capnophilic
Strong α-haemolysis on HBA
Culture may look mixed
Initial requirement for X factor
Distinguish A. actinomycetemcomitans, catalase +, from
A. aphrophilus, catalase -

104
Cardiobacterium hominis - HBA @ 48hrs
A. aphrophilus now includes
A. paraphrophilus
(V dependent strain)
Aggregatibacter
aphrophilus
gs x1000
Cardiobacterium hominis - HBA @ 48hrs
Aggregatibacter aphrophilus, HBA at 48hrs

106
Cardiobacterium hominis - HBA @ 48hrs
Aggregatibacter actinomycetemcomitans
Key features
Tiny Gram-negative coccobacilli
Capnophilic
Colonies adherent, white, dry
Fermentative
Distinguish from Brucella spp. – similar Gram stain
Distinguish from A. aphrophilus (Catalase -)

Cardiobacterium hominis - HBA @ 48hrs
Aggregatibacter
actinomycetemcomitans
gs x1000
Brucella melitensis
gs x1000
Cardiobacterium hominis - HBA @ 48hrs
Aggregatibacter actinomycetemcomitans – HBA plates @ 48hours.
Growth conditions for B. melitensis would be reversed – it is a strict aerobe!

Cardiobacterium hominis - HBA @ 48hrs
Key features
Important to recognise that this is not a campylobacter!
Gram-negative helical rods with rounded ends
Motile +++ - corkscrew
Strict anaerobe – not microaerophilic
Colonies clear, flat, spreading
Catalase -, Oxidase –
Key tests: Glucose, indoxyl acetate, nitrate, urea, H
2
S
in SIM media
Anaerobiospirillum succiniciproducens

Cardiobacterium hominis - HBA @ 48hrs
Anaerobiospirillum
succiniciproducens
gs x1000
Swarming on HBA
plate after 48 hrs
anaerobic incubation

Cardiobacterium hominis - HBA @ 48hrs
A final cautionary note~
Increasingly sophisticated identification methods are becoming
available, improving accuracy and turn around times. We
welcome these advancements which result in improved patient
outcomes.
However we must not neglect basic microbiology skills in the
belief that automation can replace them – we must recognise a
microorganism of significance before it can be identified – some
detective work and sound microbiology are required.

Thank you for listening
Thank you for listening
Any Questions?
Any Questions?